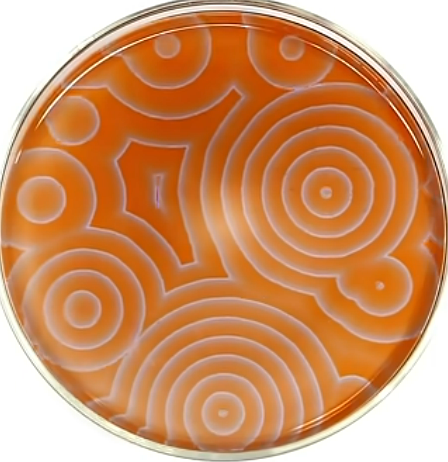

Qu’est-ce qu’un son ? Qu’est-ce qu’entendre ? Quels longs chemins évolutifs nous ont-ils menés jusqu’à ce point où nous jouissons de la musique dans le pur plaisir du massage vibratoire ? De cette émergence, comment rendre compte dans la plus grande exigence méthodologique, c’est à dire en posant a priori le nombre le plus réduit possible plus d’hypothèses et de catégories, en utilisant le moins d’axiomes ? Pour étudier la question de l’ouïe, nous nous interdirons de juger à rebours. Nous devrons tenter, autant que faire se peut, de feindre ignorer ce qu’est un son, ce qu’est la musique, ce qu’est l’entendement qui l’interprète. Plus glabre la tabula rasa d’où s’élance la question, plus dégagé l’horizon de la conjecture.
Nous nous interdirons de poser a priori, préexistant au stimulus, tout entendement, fût-il seulement un moule neutre et passif. Nous nous interdirons le credo qui ferait de l’entendement une instance préfabriquée qui n’attendrait que l’impression, le stimulus, la sensation pour construire le sens, pour percevoir, comprendre. Nous interdirons de poser à priori les catégories même de l’espace et du temps, de l’avant et de l’après, de la cause et de la conséquence.
Nous admettrons toutefois – car il faut bien admettre quelque chose pour connaître quoi que ce soit, ne serait-ce que le cogito même nimbé de brumes comme chez les animaux – que le sens se forme au contact – de quoi, comment le dire ? – et que de ce contact résultent les phénomènes. Au nombre de ces phénomènes, il faut compter tous les objets, toutes les images, toutes les représentations internes comme externes qui informent ces corps. Représentations en effet, car s’il est vrai que l’univers entier est construit sur la soupe quantique virtuelle, si l’observable entier est un brouet vibratoire, il n’y a ni moyen ni lieu de distinguer l’objet et son image, la matière et l’esprit, le sens et son contenant. Sur quelles bases sensibles assurées devrait-on admettre sans douter la partition des phénomènes en deux espèces a priori distinctes, la matière, et l’esprit ?
Or la matière pourrait-être une fiction sans pour autant nier le réel. Pour le matérialisme, la matière possède une réalité propre, externe. Schopenhauer nomme idéalisme matérialiste cette posture métaphysique a priori. Bien qu’elle traverse de part en part toute la science contemporaine, elle est rarement reconnue pour ce qu’elle est : une hypothèse implicite, aveugle et muette comme l’évidence, c’est à dire arbitraire. Hypothèse qui est de l’ordre du credo, de la foi, de la naturalisation phénoménale comme l’histoire en montre des exemples à foison, telles ces dynasties filles du soleil : le pharaon Akhénaton, fils de Rê, ou Louis XIV, le roi soleil, pour ne citer que ceux-là.
Le réel, à l’inverse, désigne la sensation au contact d’un hors-soi à jamais inconnaissable. Il y a un hors-soi, quelque chose plutôt que rien, stable et résistant. Impossible de le nier. Mais ce réel n’est jamais autrement perçu qu’à sa limite, à sa frontière, à son interface avec un percevant doué de la capacité de se relier au monde. Le type de cette interface est simple : je frappe dix, vingt, trente fois contre le mur et à chaque fois je souffre. La seule chose dont je sois raisonnablement sûr est cette douleur, non pas ce mur, sa forme, sa couleur, sa texture, toutes informations que je n’acquiers que via les sens et l’entendement.
Nous montrerons que quelques forces simples seulement, mais constamment rejouées au cours de la complexification du vivant rendent compte sans mystère du passage de la sensation primitive affectant la bactérie au sens, à la culture, à la musique. Si le monde nous apparaît d’une si stupéfiante et complexe simplicité, c’est seulement qu’à l’instar de l’éphémère ailé, il inonde l’esprit l’instant d’un clin d’œil puis plus rien. Ou bien encore à la manière de la télévision, qui montre des spectacles quand il ne s’agit que du déplacement trop rapide pour être saisi – hors du domaine humain – d’un point lumineux, et quand encore ce spectateur n’a pas étudié la mécanique ondulatoire.
Puisque nous nous astreignons à la frugalité logique, nous devrons construire de manière crédible l’espace, la durée, la causalité que nous ne posons pas à priori. Crédible, c’est à dire conforme à l’expérience, aux résultats expérimentaux reproductibles et en accord global avec les théories scientifiques contemporaines venues de divers cadrans de la connaissance : théories de l’esprit (sciences de la connaissance, neurobiologie), logique naturelle et cybernétique (oscillateurs stochastiques), biologie, éthologie, écologie, anthropologie, physique (relativité générale, mécanique quantique), théorie des nombres, théorie des graphes, fractales, topologie, chaos stochastique, flux et attracteurs, hologramme, théories morales et politiques.
Le futur a rebours

Le jugement à rebours que nous nous efforcerons d’éviter, qui plaque sur le passé les conditions du présent, est un piège redoutable d’une occurrence fréquente. Ainsi en anthropologie, l’homme ancien n’est trop souvent dans l’esprit de ceux qui y songent, qu’un homme moderne ayant vécu longtemps avant le penseur contemporain. Il ne lui manquerait pour être actuel que les connaissances accumulées entre temps: il suffirait de remplir un vase dont la forme est donnée une fois pour toute. Remplissage de connaissances tout extérieures d’un esprit qui subjectivement ne différerait en rien du nôtre
Mais est-on si sûr que les contenants de jadis et d’aujourd’hui sont vraiment les mêmes? L’homme ancien partageait-il avec nous les mêmes catégories, fussent-elles aussi fondamentales, triviales ou évidentes que l’espace, le temps, le passé, le futur ? Ou bien ces catégories ont-elles elles-mêmes une histoire, un développement ?
Si l’esprit n’est qu’un contenant à la forme définitive n’attendant en pure neutralité que d’être rempli, si Athéna naît toute cuirassée du crâne de Jupiter, il faudra alors admettre qu’avant la parole la pensée allait son train selon les mêmes modes qu’aujourd’hui. Et puisque les animaux ne sont pas doués de langage, il faudra également admettre qu’en deçà de leur mutisme, leurs pensers ne diffèrent pas des nôtres. Or si dans une certaine mesure on peut l’accepter des primates, il faudra également par récursion considérer que les catégories subjectives de la limace ne diffèrent pas des nôtres.
Or c’est bien le contraire que présentent avec une évidence croissante les disciplines de la connaissance. Le cortex, cette instance supérieure de la cognition où nous logeons concepts et pensée réflexive, a une histoire comme ont une histoire parallèle et intriquée les réflexes, sensations, émotions, gestes, images. Comment dès lors pensait-on avant le langage ? Comment communiquait-on ? Quelles images se formaient-elles dans l’esprit ? Or si le sens s’applique sur le corps, s’il se confond avec lui, il n’y a plus dès lors de monde extérieur autonome et directement accessible. Il n’y a plus d’outre-là qui contiendrait plus de vérité qu’en-deçà. La perspective est effrayante car elle interdit tout naturalisme, toute vérité extérieure et renvoie directement l’homme à sa solitude ontologique. Et c’est là probablement la raison pour laquelle l’homme préfère rester aveugle à l’idée que n’existe en dehors de lui aucune raison certaine.
L’un des lieux encore où se manifeste avec le plus de vigueur l’illusoire l’interprétation à rebours si lourde d’inconséquences philosophiques, scientifiques et pratiques est le big bang. Non pas les mesures probantes répétées depuis des décennies. Il ne s’agit pas de nier quoi que ce soit des mesures expérimentales. Mais bien de questionner l’interprétation qui en est donnée. La critique interne de la théorie elle-même invalide l’interprétation triviale du big-bang comme origine. La relativité indique en effet que lorsque la densité d’énergie du milieu est extrême – situation qui était celle présidant au big bang à t0+ ε– le temps relatif est extrêmement « ralenti » voire cesse de couler. Or si des durées relatives ne coulent pas ou pratiquement pas, il faut en conclure qu’elles n’ont pas cessé de ne pas couler ou de couler infiniment lentement. C’est proprement ce que dit la théorie : divers temps relatifs coexistent dans l’univers. On ne peut pas ne pas en conclure que ces durées sont coexistantes à notre présent terrestre local et non pas passées comme on l’entend souvent dire. Conséquemment le big bang n’est pas un passé mais bien un actuel. Ou dit autrement, il n’y a pas de durée derrière le mur de Planck.
On ajoute une couche encore d’absurdité interprétative quand prenant le train du temps à l’envers on prétend « voir » l’univers quelques « instants » après le big bang. Or quelques « instants » après le big bang, aucun humain n’existait. Il n’y eut donc jamais de situation dans laquelle un œil vît l’univers en ses balbutiements[1]. Si bien qu’affirmer que l’on aurait saisi quasi photographiquement l’univers en sa gésine – 380 000 ans « après » le big-bang – relève d’une interprétation de mystagogues pataphysiciens aux dessins ultérieurs.
Or la théorie stricto-sensu fait du big-bang l’initiateur de la durée et la condition de possibilité de l’étalon qui la mesure, l’année (qui est rappelons-le une circumambulation terrestre autour du soleil bornée par deux solstices). L’erreur consiste ici à confondre prémisse et dérivée, à expliquer la cause par sa conséquence. Erreur au fond identique à celle par quoi il est souvent affirmé que les lois physiques sont symétriques par retournement du temps : t(L)=-t(L) (où t est le temps, L une loi physique quelconque). Or c’est tout simplement là tomber dans la fiction d’une proposition logique suspendue hors du temps et hors de toute conscience, logique et conscience vivantes et mortelles [2].
La durée et ne saurait être la cause de ce dont elle est conséquence. Nous tenterons dans cet essai de ne pas succomber à l’erreur consistant à penser le passé depuis les cadres mentaux du présent. Tâche ardue et presque impossible tant le langage, naturel, symbolique, mathématique – et l’entendement sont eux-mêmes inextricablement et d’emblée engagés dans la temporalité.
[1] Voir notre texte « Un poil après le futur »
[2] On pourra se référer ici aux considérations d’Alain Connes sur les espaces non commutatifs
Presque rien, moins que tout
Ces bases posées, nous allons au moyen d’une expérience de pensée tenter d’analyser ce qu’est un son et ce mystère par quoi la musique nous enchante.
Imaginons le plus infime des animaux de la plus extrême simplicité : cellule unique, pas même nécessairement eucaryote, peut-être même dépourvue d’enveloppe. De tels organites peuvent aujourd’hui s’observer dans d’infimes diverticules argileux ou des minuscules vacuoles liquides telles qu’en recèlent les glaces polaires ou d’autres micro-milieux. Les connaissances actuelles tendent à y reconnaître de possibles sources de la biosphère.

Image: Protist Paramecium aurelia with contractile vacuoles (source: Wikipedia). La structure ici présentée est déjà extrêmement complexe en comparaison de l’organite imaginaire utilisée dans notre démonstration. Toutefois, au sein de cette structure, les vacuoles contractiles (traits noirs), réagissant à l’équilibre osmotique, ont un comportement proche de cet organite imaginaire.
Simplissime, notre organite peut-être archaïque tout aussi bien que parfaitement contemporain. Nous allons suivre en pensée ses avatars ontologiques. Cet organite n’a au départ pas de compétences. Il est au surplus dénué de tout organe des sens, de tout sens de l’espace et de la durée. Rien ne lui indique qu’il est. Pour cet animalcule, dont la masse est si faible, le milieu cyclique qui le baigne est relativement extrêmement énergétique et puissant. Une simple onde acoustique en modifie la pression interne. Outre cela, il subit un intense pilonnage photonique ; les rayons cosmiques le bombardent ; le flux et le reflux des marées gravitationnelles en barattent les entrailles, tandis qu’alternent obscurité et lumière, canicules et frimas, que changent incessamment salinité, hygrométrie…
Ces influences externes constituent, eu égard à la ténuité de notre ciron, de formidables facteurs perturbateurs. Elles sont, toutes proportions gardées, comparables à l’action de ces grosses planètes capables de malaxer les entrailles de leurs satellites au point d’en fondre les minéraux en magmas éruptifs. Tel est le rapport gigantesque entre l’organite et l’univers. Telles furent, ou plutôt telles sont, les prémisses de la vie. Telles sont et non telles furent, car, on le verra, le passé est nécessairement postérieur au présent.
Donné le gigantisme des rapports entre sujet – notre organite – et objet extérieur (tout le reste), les rapports entre fréquence propres du ciron et fréquences externes incidentes sont des « percepts » presque immédiats. L’extérieur malaxe directement le corps de l’animal. La sensation de « l’extérieur » est ainsi presque directement intuitionnée.
Or le jeu de ces influences – cosmique, stellaire, gravitationnelle, climatique, thermique…- triturant intimement la substance de l’organite, ne peut manquer de déterminer cycliquement des états remarquables selon que les influences incidentes sont en opposition ou bien en conjonction de phase avec la fréquence propre du ciron, amplifiant ou au contraire amortissant tel ou tel phénomène ou réaction métabolique, déterminant polarisations, conjonctions de phases, unissons, points d’orgue, bonaces.
D’emblée se singularisent certains régimes vibratoires : ainsi l’unisson quand intérieur et extérieur résonnent selon une proportion entière, 1,2,3… L’animalcule ainsi probablement déjà « connaît » comme sensation l’octave, le double, dont le type est un rapport de sympathie entre fréquence propre et fréquence du tout environnant quand le corps de l’animalcule vibre en harmonie avec le milieu qui le baigne.
Ainsi quelque sens du rythme et du nombre – la même chose au fond – apparaît ainsi dès la bactérie. Deux sons résonnant à l’unisson, ou bien selon des périodes doubles (à l’octave), manifestent à l’oreille humaine le nombre entier ou réel. La notion intuitive du double – 2 – de la moitié – ½ – est là tout entière en gésine. Voici naissant les nombres entiers, écho des rapports triples, quintuples, septuples… entre fréquence propre de l’organite et fréquence incidente.
Nul besoin donc de présupposer le nombre comme être ou existant, comme idée platonicienne : il est d’abord rapport sensible, intuitionné de deux grandeurs, chacune en elle-même incommensurable.
L’ouïe, fondamentalement, est une « capacité de calcul ». Elle compare un champ vibratoire interne, présent déjà aux niveaux les plus fins et le champ externe, qui s’étend du très proche jusqu’aux confins de l’univers. Toutefois, il ne peut se concevoir qu’aucun hiatus ne sépare l’organite de l’univers. Les rapports entre l’organite et son environnement sont « presque » immédiats, « presque » directs, et d’autant plus que les fréquences propres relatives de l’animalcule et du milieu englobant approchent de l’unisson. Presque : car sans ce « presque », fût-il epsilonesque, l’englobé se confondrait avec l’englobant et ne pourrait constituer un objet. Ce n’est que parce qu’entre l’univers et le percevant se maintient une tension, une différence, un soupçon d’altérité au moins, que le percevant justement se distingue du reste de l’univers. A défaut d’une singularité, il n’y ni percept, ni percevant.
Réduite à l’os, cette différence entre fréquence propre de l’organite et fréquence propre de l’englobant se confond probablement – j’en fais la conjecture – avec la constante de Planck[1], à la fois quantum d’énergie, quantum d’information et durée source.
Ainsi pour l’animalcule déjà une distance se sent, reflet de ses cyclicités propres face aux cyclicités globales ou au contraire fines des « objets » qui l’environnent. Chacune de ces cyclicités est intrinsèquement incommensurable, propre à chaque objet et en marquant l’existence singulière, cet objet fût-il l’univers lui-même. Mais bien qu’intrinsèquement incommensurable chacune en elle-même, leur croisement détermine une durée et un lieu réels, manifestes, et donc la possibilité d’une métrique locale. Cette distance/durée est assimilable à un gradient d’énergie, toujours orienté dans le même sens, de l’extérieur, d’où provient l’énergie, vers l’intérieur, qui la consomme. On nomme généralement ce gradient flèche du temps. A tort, pour la raison que le mot « temps » ne recouvre aucune réalité de l’univers. Seuls s’y distinguent l’instant et la différence élémentaire entre le soi et l’hors-soi.
[1] Quelle est la signification des constantes cosmologiques ? Sont-elles des sortes de « nombres architectes », nombres architectes au nombre nécessairement d’une poignée seulement, et dont les produits architectoniques se verraient au sein des nombres sous forme de nombres « univers », « imaginaires », « premiers », etc. Notons en passant que la dimension de Planck n’adopte ses valeurs bizarres et pas très élégantes – 1,616 × 10-35 mètre, 2,177 × 10−8 kg, 5,391 × 10−44 s ,1,875 × 10−18 C, etc – que parce qu’aperçue, ex-post, depuis ses conséquences, et non depuis son in-ception, nécessairement hors d’atteinte de l’entendement, puisque condition de possibilité de l’aperception. On pourrait bien comme à C, lui accorder la valeur unitaire 1.
Morula

Notre cellule flotte dans l’océan. Au-dessus d’elle tournoie la voûte céleste, s’entrechoquent les galaxies, explosent les supernovae. Des branes cinglent l’univers de part en part en quelques battements, tandis qu’à des niveaux plus fins l’agitation brownienne triture infatigable la soupe de particules bouillonnant et grumèlant depuis le « vide » quantique, instable et gorgé d’énergie. Voilà ce qu’est, pour notre morula, l’univers. Voilà ce qu’il est pour nous aussi, même si de sa réalité profonde nous n’entrevoyons que ce qui est d’emblée utile à notre pérennité phénoménale.
Notre morula ne peut être transparente. Elle est au moins diaphane. Car nécessairement, à quelque niveau, elle transforme la portion d’univers qui l’accueille. Un corps imaginaire, totalement transparent à tous les rayonnements, se laisserait traverser sans altérer le champ incident. Un corps battant à l’unisson de tous les champs vibratoires, n’interagissant aucunement avec son environnement, ne pourrait du fait même de sa parfaite consonance avec ce qui n’est pas lui, développer une quelconque instance de relation avec un extérieur envers lequel il n’entretient aucune différence de potentiel, aucune arythmie, aucune syncope, aucun glissement, aucune solution de continuité. De fait aucune existence, aucune perception ne sont envisageables sans une différence d’avec le milieu, même la plus infime.
Plongé dans un champ vibrant, un corps réagit en adoptant un mode vibratoire particulier, synthèse dynamique du champ incident et des caractéristiques singulières de l’objet. En retour il modifie le champ incident à la manière dont, dans les jardins Zen les ondes de gravier heurtent et contournent les rochers en en soulignant les contours, ou bien encore à la façon dont la pluie solaire aux abords de la terre toronne au sein de la ceinture de Van Allen.
Le décalage entre mode vibratoire propre de l’organite – sa fréquence propre de résonnance – et la mer vibratoire qui l’englobe, fournit la condition de possibilité du développement d’un organe du sens. Cet écart, aussi ténu soit-il, constitue la racine du sens, la condition de possibilité de la construction d’un soi et d’un hors-soi primitifs. La discontinuité du milieu manifeste et délimite la singularité, discontinuité qui est la condition de possibilité de l’émergence d’un organe de relation au monde, d’un organe des sens.
Parler de vibration, c’est interdire l’arrêt. Il n’y a pas de vibration statique, même si localement deux ondes en opposition de phase créent une immobilité virtuelle. Entre l’organite et son environnement circule sans cesse une théorie d’états miroir, par lesquels l’organite ajuste son mode vibratoire aux influences incidentes dans des figures dont le camaïeu complexe – les Moires des vieux Grecs – reflète la structure et les relations entre en-soi et hors-soi. De sorte qu’organite et environnement, en soi et hors soi, intègrent tous deux à chaque instant tous les états de l’univers[1]. Ainsi peut-on dire de la même manière, avec certes quelque approximation, que le mouvement d’une molécule de l’océan reflète et intègre l’ensemble des mouvements de la masse océanique.
Outre un corps, notre organite comporte une limite, une frontière, en deçà de quoi finit l’en-soi, au-delà de quoi commence l’hors-soi. Il n’est pas même nécessaire que cette limite soit matérialisée par une membrane, une enveloppe. Elle peut n’être qu’une solution de continuité en deçà et au-delà de quoi diffèrent nature physique (densité, d’élasticité, comportement dynamique, etc.) ou chimique (salinité, acidité…)
Cette enveloppe, remarquons-le est bidimensionnelle, quand le vitellus est tridimensionnel. Ainsi le régime vibratoire de la limite diffère-t-il nécessairement de celui de la masse de l’organite. Aux modes vibratoires tridimensionnels rétroagis de l’en-soi et de l’hors-soi se superpose le mode vibratoire bidimensionnel de l’enveloppe. De sorte que le sens du « dedans » et du « dehors » émerge du comportement original de la limite. L’embryologie le confirme, qui observe une origine commune au système nerveux (encéphale, moelle épinière, plexus, nerfs) et à la peau, conçue comme un prolongement périphérique du cerveau. Cette peau-limite recèle en puissance les éléments d’une théorie[2] de l’espace, sens dont, par hypothèse, notre organite n’était pas au départ doué.
Vibrer emporte encore une conséquence importante. Vibrer interdit le repos. Le corps de notre organite, incessamment soumis à une myriade d’influences périodiques, n’est jamais quiet.
Ainsi dans le cas d’une onde acoustique, alternance de pression et de relâchement, le corps de notre animalcule se voit alternativement comprimé puis étiré. En sorte que l’état énergétique de notre organite n’est jamais « consécutivement » semblable. Pour le ciron, cela n’est pas sans conséquence : il lui faut réguler continuellement à la fois l’accroissement d’énergie potentielle et sa dissipation. Or il n’est pas interdit de supposer que certains états sont pour notre animalcule plus « confortables » tandis que d’autres le sont moins : plus « confortables » quand le métabolisme de notre organite se trouve amélioré, « inconfortable » quand il se trouve à l’inverse dégradé.
[1] L’étoffe de l’espace-temps est bien cela : une collection infinie de centres où se jouent des espace-temps singuliers, barycentres de l’ensemble des influences externes et de la source interne. L’agrégat synthétique de tous ces barycentres donnent l’illusion d’un espace-temps externe universel, qui n’a pas en soi de réalité.
[2] « Théorie de l’espace » au sens où l’on dit « théorie de l’esprit », dans les deux cas avec abus, puisqu’il ne s’agit pas de théorie à proprement parler – procession logique de concepts rationnels et conscients plus ou moins conformes à l’expérience – mais de théorie implicite et inconsciente par quoi se forment les perceptions, concepts, affects et jugements
Translucence
Notre cellule flotte dans l’océan. Au-dessus d’elle tournoie la voûte céleste, s’entrechoquent les galaxies, explosent les supernovae. Des branes cinglent l’univers de part en part en quelques battements, tandis qu’à des niveaux plus fins l’agitation brownienne triture infatigable la soupe de particules bouillonnant et grumèlant depuis le « vide » quantique, instable et gorgé d’énergie. Voilà ce qu’est, pour notre morula, l’univers. Voilà ce qu’il est pour nous aussi, même si de sa réalité profonde nous n’entrevoyons que ce qui est d’emblée utile à notre pérennité phénoménale.
Notre morula ne peut être transparente. Elle est au moins diaphane. Car nécessairement, à quelque niveau, elle transforme la portion d’univers qui l’accueille. Un corps imaginaire, totalement transparent à tous les rayonnements, se laisserait traverser sans altérer le champ incident. Un corps battant à l’unisson de tous les champs vibratoires, n’interagissant aucunement avec son environnement, ne pourrait du fait même de sa parfaite consonance avec ce qui n’est pas lui, développer une quelconque instance de relation avec un extérieur envers lequel il n’entretient aucune différence de potentiel, aucune arythmie, aucune syncope, aucun glissement, aucune solution de continuité. De fait aucune existence, aucune perception ne sont envisageables sans une différence d’avec le milieu, même la plus infime.
Plongé dans un champ vibrant, un corps réagit en adoptant un mode vibratoire particulier, synthèse dynamique du champ incident et des caractéristiques singulières de l’objet. En retour il modifie le champ incident à la manière dont, dans les jardins Zen les ondes de gravier heurtent et contournent les rochers en en soulignant les contours, ou bien encore à la façon dont la pluie solaire aux abords de la terre toronne au sein de la ceinture de Van Allen.
Le décalage entre mode vibratoire propre de l’organite – sa fréquence propre de résonnance – et la mer vibratoire qui l’englobe, fournit la condition de possibilité du développement d’un organe du sens. Cet écart, aussi ténu soit-il, constitue la racine du sens, la condition de possibilité de la construction d’un soi et d’un hors-soi primitifs. La discontinuité du milieu manifeste et délimite la singularité, discontinuité qui est la condition de possibilité de l’émergence d’un organe de relation au monde, d’un organe des sens.
Parler de vibration, c’est interdire l’arrêt. Il n’y a pas de vibration statique, même si localement deux ondes en opposition de phase créent une immobilité virtuelle. Entre l’organite et son environnement circule sans cesse une théorie d’états miroir, par lesquels l’organite ajuste son mode vibratoire aux influences incidentes dans des figures dont le camaïeu complexe – les Moires des vieux Grecs – reflète la structure et les relations entre en-soi et hors-soi. De sorte qu’organite et environnement, en soi et hors soi, intègrent tous deux à chaque instant tous les états de l’univers[1]. Ainsi peut-on dire de la même manière, avec certes quelque approximation, que le mouvement d’une molécule de l’océan reflète et intègre l’ensemble des mouvements de la masse océanique.
Outre un corps, notre organite comporte une limite, une frontière, en deçà de quoi finit l’en-soi, au-delà de quoi commence l’hors-soi. Il n’est pas même nécessaire que cette limite soit matérialisée par une membrane, une enveloppe. Elle peut n’être qu’une solution de continuité en deçà et au-delà de quoi diffèrent nature physique (densité, d’élasticité, comportement dynamique, etc.) ou chimique (salinité, acidité…)
Cette enveloppe, remarquons-le est bidimensionnelle, quand le vitellus est tridimensionnel. Ainsi le régime vibratoire de la limite diffère-t-il nécessairement de celui de la masse de l’organite. Aux modes vibratoires tridimensionnels rétroagis de l’en-soi et de l’hors-soi se superpose le mode vibratoire bidimensionnel de l’enveloppe. De sorte que le sens du « dedans » et du « dehors » émerge du comportement original de la limite. L’embryologie le confirme, qui observe une origine commune au système nerveux (encéphale, moelle épinière, plexus, nerfs) et à la peau, conçue comme un prolongement périphérique du cerveau. Cette peau-limite recèle en puissance les éléments d’une théorie[2] de l’espace, sens dont, par hypothèse, notre organite n’était pas au départ doué.
Vibrer emporte encore une conséquence importante. Vibrer interdit le repos. Le corps de notre organite, incessamment soumis à une myriade d’influences périodiques, n’est jamais quiet.
Ainsi dans le cas d’une onde acoustique, alternance de pression et de relâchement, le corps de notre animalcule se voit alternativement comprimé puis étiré. En sorte que l’état énergétique de notre organite n’est jamais « consécutivement » semblable. Pour le ciron, cela n’est pas sans conséquence : il lui faut réguler continuellement à la fois l’accroissement d’énergie potentielle et sa dissipation. Or il n’est pas interdit de supposer que certains états sont pour notre animalcule plus « confortables » tandis que d’autres le sont moins : plus « confortables » quand le métabolisme de notre organite se trouve amélioré, « inconfortable » quand il se trouve à l’inverse dégradé.
[1] L’étoffe de l’espace-temps est bien cela : une collection infinie de centres où se jouent des espace-temps singuliers, barycentres de l’ensemble des influences externes et de la source interne. L’agrégat synthétique de tous ces barycentres donnent l’illusion d’un espace-temps externe universel, qui n’a pas en soi de réalité.
[2] « Théorie de l’espace » au sens où l’on dit « théorie de l’esprit », dans les deux cas avec abus, puisqu’il ne s’agit pas de théorie à proprement parler – procession logique de concepts rationnels et conscients plus ou moins conformes à l’expérience – mais de théorie implicite et inconsciente par quoi se forment les perceptions, concepts, affects et jugements
Les racines du temps
Ainsi, la vibration, en ce qu’elle est pour notre protozoaire alternance d’états internes distincts, ouvre la possibilité d’une distinction dynamique dans la succession des états, et introduit la possibilité de la construction de ce qui, à des degrés de complexité supérieurs, deviendra la durée. La discrimination minimale entre deux niveaux énergétiques « perçus » affectant notre organite doit être considérée comme durée-racine (la durée spécieuse des philosophes, en ce sens qu’elle n’est qu’apparente et non pas intrinsèque). Là encore cette durée racine renvoie probablement au nombre de Planck.

Supposer la variabilité dynamique à l’origine de la durée ne revient-il pas, toutefois, à reconnaître tout simplement qu’elle est déjà présente dans l’onde incidente affectant notre protozoaire ?
Mais que pourrait bien être la durée d’un son que personne n’entend, pas même un organite ? Pour Angelus Sibelius, la rose est belle sans raison pour elle-même. Pour Ronsard, elle est le moyen de tenter d’obtenir les faveurs de Cassandre et transmettre ses gènes. Mais sans Ronsard ni Sibelius, la rose n’a pas même de nom, voire pas même d’existence, historique au moins. Le tsunami comme la vague ne déferlent qu’en tant qu’ils rencontrent un obstacle. Parler de direction de propagation d’une onde, c’est implicitement faire référence à un observateur regardant passer le train d’onde. Ce n’est qu’en référence à cet observateur qu’une direction au train d’onde peut se reconnaître, tout comme d’ailleurs son origine
Ainsi en va-t-il de tout système vibratoire, big-bang compris, qui ne serait ni big ni bang sans homo pour lui donner un nom. On peut, fort classiquement depuis Einstein, comparer la situation à un train filant sur ses rails. Soit on en est le passager et il n’y alors pas de mouvement, hors accélérations et décélérations, pas de durée. Soit nous sommes les vaches au bord de la voie, et c’est à grande vitesse que nous voyons filer le bolide.
Ce n’est que par rapport à un récepteur extérieur doué d’un en-soi, alternativement comprimé puis déprimé, que l’onde incidente acquiert pour lui un sens, une flèche et à vrai dire une durée.
Un tel système train/vache nous est familier si l’on considère qu’on peut en remplacer les termes, l’un par le photon, l’autre par nous même, c’est à dire ce système percevant constitué de l’ensemble (rétine-encéphale)/(personne). Tout comme le tsunami ne devient vague scélérate qu’en percutant la rive tandis qu’au vaisseau de haute mer elle n’est qu’un souple bombement, il importe de remarquer que le photon ne délivre son message venu prétendument d’époques lointaines que lorsqu’il percute hic et nunc un obstacle, une rétine par exemple.
Car lorsqu’il glisse dans le vide à une vitesse proche de la vitesse limite C, il le fait, nous dit la théorie de la relativité, dans un espace temps qui lui est propre et d’où la durée est quasi abolie. Il ne transporte lors rien qui ressemble à une information « historique » qui compterait le temps à la façon d’une horloge. Ce photon, qui n’emporte avec lui aucune durée intrinsèque, sinon la durée totale indéterminée, est pourtant le vecteur qui en touchant notre rétine apporte à notre encéphale, puis notre entendement, enfin notre conscience l’information « du temps qui passe ». C’est cette percussion, ce contact, cette interaction, qui construisent les catégories réactives de l’espace et de la durée. C’est ce photon et la cohorte de ses pareils qui dans l’interception, et dans l’interception seulement, dessinent l’image spécieuse d’une explosion initiale. Mais s’il arrive que ce photon ne rencontre aucun obstacle, alors il erre infiniment dans l’instant [1]. Combien sont-ils de cette espèce ?
[1] Le neutrino, qui interagit très peu avec la matière et traverse de part en part le globe comme on se joue est d’ailleurs du point de vue de l’instantanéité éternelle un bien meilleur candidat.
Lire la suite : ouïr et durerLe sprint de la tortue
L’interaction fondamentale entre photon et récepteur est hors durée, instantanée dans le sens où la durée est pour l’interaction une dimension sans pertinence, pour cette raison que l’interaction même est générative de la durée. La théorie de l’information indique qu’il ne saurait exister transfert d’information sans quelque échange d’énergie, de moment, de matière… Cet échange génésique, par la nécessité fondamentale que nous venons d’indiquer, est achronique. Il ne devient durée que dans les conséquences de l’interaction. Or si l’on veut s’arrêter à l’évidence – cette dimension à la fois symplectique et terriblement ardue à décrire tant elle est limpide, lisse et dépourvue de prises où accrocher l’entendement – c’est bien en totalité dans l’instant présent que s’expriment devant le miroir de mon être l’ensemble des phénomènes, même si leur description, dont le prototype est la représentation intérieure s’inscrit nécessairement dans la durée qu’elle génère. Le présent instantané est bien l’instance ressentie la plus directement par chaque être conscient. La durée n’est que seconde à cette évidence.
En sorte qu’il faut reconnaître que le passé n’est pas antérieur au présent. Non : le passé repose sur l’instant comme une pyramide retournée sur son pyramidion. De manière significative, certaines populations méso-américaines considèrent que le passé est devant – puisqu’on le voit et en connaît les vicissitudes – tandis que le futur, opaque, aveugle et inconnu, se situe lui derrière.
La durée est une représentation fortement ultérieure, fortement construite, fortement synthétique, fortement charpentée de chaînes de conséquences et consécutions d’images. Ainsi au témoignage des techniques d’exploration in vivo de la dynamique cognitive, la durée des évènements psychologiques élémentaires est de l’ordre de l’atto-seconde (10-18 seconde). Le temps de prise de conscience bat lui sur le tempo du dixième de seconde. Pour rendre ceci plus parlant, disons que si l’on dilatait l’atto-seconde pour la rendre aussi « longue » qu’une seconde, la durée séparant l’interaction initiale photon/rétine de la vision consciente, cette durée s’étalerait sur quelque 300 milliards d’années. Ainsi quand nous prenons conscience d’avoir perçu, cette perception est déjà fort ancienne, vieille d’une scansion ayant battu, agrégé, composé, déployé des trillards de milliards d’évènements élémentaires.
La sensation, le percept, la représentation, le concept contiennent dès lors une information temporelle que l’événement élémentaire – le photon au point d’impact – immobile en soi dans sa glissade infiniment célère, ne contient pas. Le photon parcourt immobile l’univers tandis que la durée se génère dans l’interaction avec un corps tiers, comme la vague déferlant sur l’obstacle.

La durée est une représentation fortement ultérieure, fortement construite, fortement synthétique, seconde seulement à l’émergence phénoménale, non pas sa racine, non pas l’éther dans lequel baigneraient les évènements. Il réside donc dans le temps une forme de tautologie circulaire. Le langage, ou les systèmes de signe, code ou mathématique, en sont de part en part englués, de sorte que s’extraire de cette tourbe signant la frontière entre physique et métaphysique est une gageure que seule l’émotion artistique, et singulièrement musicale, constitue une gageure. On effleure ici cette notion fort subtile, que le langage propositionnel (articulé, théorématique), à la différence de l’évocation poétique et singulièrement musicale, capte si mal: flux et mouvement ne se recoupent pas. L’onde se propage sans déplacement de matière. Le flux se soutient sans mouvement, hors de toute durée. Voilà pourquoi Alice doit courir pour rester sur place. Voilà pourquoi à l’issue d’une chute vertigineuse elle poursuit sans impact sa course horizontale.
Jeté de dés
Revenons à notre protozoaire plongé dans sa soupe vibratoire. Nous l’avons doté – ou plutôt cette dotation s’est dotée elle-même – de caractéristiques remarquables : en soi/hors soi, embryon d’espace, de durée, de sens. Deux états s’y singularisent. Dans l’un notre organisme vibre en harmonie avec son environnement : sa fréquence propre est un multiple du champ incident. Dans l’autre, à l’inverse, l’organite vibre en décalage ou en opposition de phase avec l’extérieur.
Harmonie ou opposition de phase, on l’a dit, ne sont pas sans conséquences sur la dynamique interne de notre vibrion, son métabolisme[1]. Le régime harmonique peut-être comparé à quelque massage limitant les tensions internes et favorisant l’apparition d’états stables, tandis que la dissonance provoquerait strictions, régimes turbulents, dissipations énergétiques accrues, ruptures des liaisons mécaniques ou chimiques. L’animal harcelé de trop de perturbations extérieures disparaîtra. Le plus favorisé croîtra et multipliera.
Quelques éons plus tard, à cette discrimination toute subie et passive dont la conséquence est la survie ou la disparition, succède la capacité à distinguer l’harmonie de la dissonance, c’est à dire à se déplacer afin de choisir l’environnement le plus favorable. Quoi qu’il en soit, qu’elle se manifeste activement ou passivement, voilà notre animalcule doté d’une capacité de discrimination (dont l’une des composantes est spatiale) bien que cette capacité ne renvoie au fond qu’à la bifurcation initiale productrice de la singularité, à la première interaction, quelque chose surgissant de l’amorphe, s’extrayant du « vide », manifestant quelque jeté de dés. L’événement s’est produit et finira un jour, à force de reproduction, composition, multiplications, réplications, éploiements, par produire des humains outrecuidants qui auront tout oublié de leur origine de hasard et se prétendront intelligents, conscients et libres. Mais n’anticipons pas.
Tout modeste et primitif qu’il soit, voici notre organite doté de la capacité logique, active ou passive, à distinguer deux états, l’un favorable, l’autre néfaste. Il se comporte comme une porte logique : harmonique = 1 ; turbulent = 0. S’il est une cellule souche, l’un de ses possibles descendants sera peut-être un neurone. Assemblés en un cerveau, ils incrémenteront cette capacité élémentaire à la puissance des 100 milliards que le cerveau en comporte, chacun doté de 10 000 axones se terminant chacun par une synapse, dont le fonctionnement est lui-même d’une extrême complexité [2], selon la perspective abyssale d’un aster ou chaque élément d’une série infinie est lui-même une série infinie, à l’instar des paysages vertigineux que peignent Mandelbrot ou Cantor ou. On peut ainsi estimer avec ce dernier que cerveau et univers ont du point de vue de la complexité une puissance égale. Et l’on peut dire ainsi que l’un reflète l’autre et le contient, et réciproquement, à l’instar de ces géométries de Von Neumann où en quelque partie qu’on divise et divise encore et encore un espace, il reste identique à lui-même.

Quoi qu’il en soit, par le fait qu’il survit là où l’environnement lui est favorable et disparaît ailleurs, notre organite porte-logique commence à compter : favorable l’unisson, favorable l’octave, profitable l’entier, tonique l’irrationnel, défavorable le décalage de phase, nuisible la dissonance, toxique la cacophonie, synonyme de désordre biologique. Les série harmoniques biotiques, dont les exemples sont foison, expliqueraient-elles pourquoi la musique nous procure plaisir voire extase [3]?
Pour notre organite, l’une des solutions de survie possible, lorsqu’un environnement jusqu’alors favorable devient toxique, s’assèche ou s’appauvrit en nutriment, est de déménager ses pénates. Là encore, il ne s’agit pas de volition, mais simplement de conjonctions de circonstances, à la croisée des modifications internes et externes, dont le résultat stupéfiant peut paraître résulter d’une intention par la seule raison de la médiocrité de notre entendement et de l’extrême brièveté de son empan.
Déménager : car soit en effet l’animalcule baigne passivement dans un flux – flux nécessairement afin que se renouvèlent sans cesse l’apport en nutriments sans quoi l’environnement périphérique se tarirait rapidement – soit ce flux est acquis. « Acquis » en ce sens que le protozoaire, la grappe biologique, l’organisme, se sont organisés pour susciter un flux les traversant. L’amibe se forme en tube suscitant un courant et donc un gradient alimentaire. Cette cheminée d’un coup brise la symétrie sphérique de l’être unicellulaire dont toute l’enveloppe concourt à des échange radiaux, sans que se distingue guère d’autres espaces qu’intérieur et extérieur, pour basculer vers une symétrie où s’affirme nettement une bouche et un excrétoire, un avant – capter , aspirer, avaler , susciter le flux – et un arrière – excréter, éliminer, se débarrasser des scories du processus. Dès lors, ce flux orienté distingue une bouche et un rectum, un devant et un derrière, un avant et un après. Dès lors l’espace se crée et s’oriente dans une indissociabilité d’avec la durée que retrouve la célèbre formule limite d’Einstein affirmant qu’E=mC2 . C2 et non pas (d/t)2, d et t étant les deux faces d’une même et unique réalité[4].
[1] « Métabolisme » qui peut, nous l’avons dit, se résumer à une différence de densité, de chiralité…
[2] Voir notre texte : « Assis au bord d’une synapse »
[3] Au moment où j’écrivis ces lignes j’ignorais les travaux, très conjecturaux mais éclairants, de Joël Sternheimer sur les protéodies.
[4] « d » étant l’espace et « t » la durée, ou plus exactement leur mesure dans une métrique donnée nécessairement ex_post, arbitraire et subjective, fût-elle assise sur le battement du césium.
Sarvam dukham
Poursuivons l’étude métabolique de notre vésicule. Remarquons qu’elle ne peut se comporter que comme un accumulateur d’énergie. Si en effet, elle dissipait l’intégralité de l’énergie reçue, l’animalcule n’en serait plus un, car rien ne le distinguerait plus alors du milieu ambiant.
Le simple fait de constituer un globule, amas, vessie, d’une nature physique différente de l’hors soi, quelque ténue soit la différence, implique un glissement du rayonnement incident vers des fréquences supérieures, plus énergétiques. Cet amas, ce globule, cette vessie agissent comme des lentilles optiques ou des capacités électriques. Le phénomène s’amplifie encore dès que l’animalcule se dote d’une membrane-limite agissant comme résonateur autonome.

La vie, de fait, implique une distinction en terme de niveau énergétique entre l’inerte englobant et le soi vivant. Il s’agit là à la fois d’une condition d’existence et d’une contrainte.
– Condition d’existence, en ce sens que l’organisme vivant présente nécessairement des caractéristiques le distinguant nettement, en terme de température, structure, composition chimique, de son environnement, distance sans quoi il ne se différencierait pas du fond de l’univers.
– Contrainte, en ce que cette altérité se manifeste au sein de l’organite par des frictions mécaniques – des turbulences par exemple – ou encore une température interne supérieure à celle de l’environnement, température dont on sait qu’elle traduit une agitation brownienne accrue et donc une stabilité chimique détériorée.
Voilà pourquoi biologistes et thermodynamiciens, Ilya Prigogine en tout premier lieu[1] considèrent que la vie est un phénomène loin de l’équilibre. Est souligné ainsi le saut séparant l’inerte de la vie. Celle-ci maintient avec le milieu des échanges intenses, celui-là – un caillou par exemple – n’en ayant que de fort limités. Ceci explique notamment la stabilité des pigments minéraux, la beauté des couleurs fraîches et vives de la grotte Chauvet ou celle de Lascaux plusieurs de dizaines de milliers d’années après qu’on les a peintes.
L’impératif d’écart à l’équilibre du vivant et la topologie de l’espace-temps entretiennent des rapports profonds. En effet, espace et temps, avant, après, maintenant, devant, derrière, bouche, anus, consommation, consummation, être, ne pas être, cause, conséquence, sont en connexion profonde avec l’écart néguentropique que doit maintenir le vivant qui ne se soutient que dans le flux.
A la différence de l’espèce minérale, le vivant ne se maintient tel que parce que subsiste avec son environnement un gradient énergétique, un potentiel garantissant la continuité du flux d’énergie ou de nutriments. Le vivant est consommateur d’énergie qu’il transforme en ordre, dans une stricte équivalence entre énergie et information.
Remarquons que cet ordre – polarité de l’animal globule, devant/derrière – avant/après de l’amibe tube – s’acquiert par la consommation et la consumation d’un flux sous-jacent en lui-même non caractérisable.
Cette contrainte à consommer pour se maintenir, cette contrainte à susciter un flux constant est le propre de la vie. Les mythes évoquent ces relations très profondes : c’est ainsi que le corps du Christ est mystiquement consommé durant l’eucharistie.
Sans le flux le vivant ne peut se maintenir. Néguentropie et second principe de la thermodynamique – toute structure, montagne ou homme, évolue vers la destruction de l’ordre qui la caractérise – sont liés. Si bien que cette consumation qu’est la vie se fait au prix d’un flux impérieux de larges quantités d’énergie. Tout l’effort de la vie est de maintenir toujours, le plus stable possible, le flux optimum nécessaire à stabilité dynamique. Bien manger, bien boire sans grand souci du lendemain, voilà l’idéal du vivant. Mais il en va rarement ainsi. Il faut aller chercher le flux, il faut arracher à la terre sa propre subsistance, il faut éviter d’être soi-même ce qui soutiendra le flux vital du prédateur. La sécheresse, la faim sont associé dès le stade de la bactérie à l’effort de vivre. Voilà comment en termes thermodynamiques et néguentropiques s’interprète le premier jugement bouddhiste sarvam dukham : tout est douleur. Par le fait de vivre loin de l’équilibre, la bactérie, l’escargot, le chevreuil, l’homme souffrent. Le travail, de la femme qui donne la vie, celui nécessaire à l’acquisition de la nourriture renvoient en écho à l’effort néguentropique, à la douloureuse nécessité du gradient énergétique, au feu lent qui à la fois consume l’être et le maintient en vie. Voilà comment s’intuitionnent directement, pour chacun, les grands mystères de l’univers, dont les lois et les nécessités ne souffrent pas d’exception : conservation de l’énergie, du mouvement, du moment, dégradation, recréation, entropie/néguentropie, douleur, travail[2].
[1] Ilya Prigogine qui écrivit, en collaboration avec son étudiante Isabelle Stenghers, la Nouvelle Alliance, ouvrage touchant à certains des sujets abordés ici. I. Stenghers poussa trop loin pourtant l’intrication nature/culture finissant par abolir la tension entre ces deux pôles pour caresser des idées plus proches du néo obscurantisme « woke », du tarot de Marseille et de la sorcellerie, que de la science.
[2] D’où la nécessité de rendre le travail le moins pénible possible, d’en réduire l’astreinte autant que possible, de la dégager de la brutalité animale et archaïque de l’exploitation
Néguentropie
La vie comme phénomène loin de l’équilibre car en effet les niveaux énergétiques qu’atteignent les organismes vivants se traduisent par une agitation brownienne accrue entraînant une dégradation accélérée des structures du vivant. Ainsi la perdurance de la structure caractéristique du vivant implique paradoxalement que ce vivant se place d’abord dans un état accroissant les menaces de dégradation de son intégrité. Tel est le prix de la création d’ordre. Tel est le prix de la violation apparente du second principe de la thermodynamique – toute structure évolue vers la dégradation de l’ordre qui la caractérise – que cette structure soit montagne, qui finira par s’ébouler, ou organisme vivant voué à la mort et à la décomposition humique.
La vie pour se maintenir doit donc à la fois perpétuellement échanger avec son environnement pour acquérir et de l’énergie et les éléments qu’elle ne peut synthétiser elle-même, tout en dissipant l’énergie excédentaire et excréter les métabolites de dégradation. Ainsi la singularité biologique se trouve tendue entre des exigences antagonistes : minimiser son énergie interne tout en la maintenant à un niveau suffisant pour perdurer en tant que singularité. Entre ces antagonismes pratiques, véritables apories tant physiques que métaphysiques, la vie établit divers compromis dont il est illusoire de supposer qu’ils sont toujours optimaux. Y a-t-il une différence minimale en deçà de quoi le vivant ne peut apparaître ou se soutenir ? Une fois encore vers, le seuil de Planck, qui traduit à la fois une notion temporelle – seuil sur lequel bute la théorie récessive du big-bang – et également une quantité d’espace et d’information, semble fournir une indication pertinente. Ainsi ce quantum, vu sous l’angle de l’énergie, est la quantité d’énergie minimale nécessaire pour que quelque chose se produise, pour qu’un un événement en soit un, pour qu’une information émerge, pour qu’il existe quelque chose plutôt que rien.
L’organite, conséquence de sa singularité physique et énergétique, ne perçoit pas directement l’univers, mais seulement sa transposition égotique. Soumis à un rayonnement, un champ, une vibration, il résonne en réponse, mais sur un mode ou selon des fréquences. Jamais la chose en soi n’est directement saisie, mais toujours interprétée. L’idée d’une « chose en soi » n’a ainsi de valeur que purement négative: quelque chose résiste, s’impose, sans que jamais cette « chose », cet objet puisse être caractérisée autrement que négativement. Il n’y a pas de physique, comme objet distinct, séparé, connaissable, ce que manifeste avec éclat, en français, le double genre du mot physique, renvoyant tantôt à la chose en soi – LA physique -, tantôt à l’existence sensible vécue de l’intérieur – LE physique. Par quelque contorsion intellectuelle qu’on aborde la question, on ne peut qu’admettre que jamais ne nous sera accessible que le pan physique sui generis, centrifuge de l’univers : la physique ne s’interprète qu’au travers du physique. Les conséquences scientifiques, culturelles, politiques, sociales, pratiques d’un tel constat sont immenses.

Quid du qu’ouïs-je ?
Notre appareil sensoriel manifeste avec éclat l’hétérogénéité entre les deux genres de la physique. Ainsi, bien que les fréquences lumineuses soient distribuées au long d’un continuum de fréquences, l’impression colorée nous apparaît pour sa part composée de trois couleurs dites primaires, qui n’ont en réalité pas de contrepartie dans LA physique, même si dans LE physique, elles s’incorporent dans trois types de cellules, chacune sensible a l’une des section du continuum (rouge, vert, bleu chez l’humain). La perception s’organise autour de trois pôles en discrétisant arbitrairement le phénomène externe intrinsèquement continu.
Cette discrétisation de l’amorphe, cette partition arbitraire du continu, autrement dit la création de formes, renvoie probablement tant à la nécessité qu’à l’avantage adaptatif. Nécessité de reconnaître le poison – significativement les animaux toxiques se parent de couleurs balise, tel le noir strié de jaune – ou bien au contraire le comestible. Il y eut avantage à distinguer un fruit rouge, mûr, digeste, au sein de la mer verte du feuillage, avantage à distinguer au sein du continuum certaines oppositions pertinentes.
Les fruits mûrs ne furent pas d’abord rouges. Ils le devinrent par un processus de sélection évolutif par lequel l’entendement leur conféra cette propriété – être rouge – car elle était pour lui avantageuse. Au surplus, cette association dans l’œil du consommateur – couleur, maturité, nutritivité – a assuré une dispersion relativement plus efficace des graines de fruits murs rouges, de telle sorte que dès qu’ils furent identifiés et reconnus comme profitables au cueilleur –qui ingère et brûle à son profit l’énergie potentielle y contenue [1]– ce dernier assura leur dispersion différentielle au détriment d’autres formes dont il ne tirait pas tant d’avantages.
Pour la vessie gélatineuse qu’est notre ciron, les sons et vibrations qui le baignent déterminent des régimes vibratoires, dont certains lui sont favorables, d’autres défavorables. Ainsi émerge la possibilité d’une discrimination endogène des divers états, selon qu’ils soutiennent plus ou moins bien l’activité biologique. Cette faculté, répétons-le, n’est en fait que la surdétermination de la discrimination de l’impératif néguentropique essentiel, en deçà de quoi la singularité se confondrait avec l’univers englobant.
Se distinguer comme quelque chose sur le fond de l’univers, traverser des états plus ou moins favorables sont des conséquences de la première rupture de symétrie, de la première bifurcation, du premier événement, par quoi quelque chose est plutôt que rien. Cette première conséquence s’identifie à la durée intrinsèque : elle est la différence minimale au-delà de quoi quelque chose survient, en deçà de quoi toute discrimination perd sens. Elle détermine la possibilité d’autres conséquences, d’autres événements.
Cette première conséquence ne peut avoir de flèche, de même qu’un espace ne comportant qu’un point singulier ne fournit aucune structure susceptible de soutenir un vecteur orienté. La durée n’acquiert une flèche que composée avec les évènements ultérieurs, condition de possibilité d’apparitions de formes, structures, sens. Il s’agit d’une construction auto-générative se déployant dans un espace auto-construit qui se déploie en acquérant des propriétés que nous appelons espace-temps. Cet espace n’a pas de point d’insertion, pas d’origine : il surgit d’un lieu aveugle qui à jamais restera hors de portée de la connaissance, car il est la condition de possibilité de toute connaissance.
Dès posées donc, ces premières et secondes conséquences déchaînent en une explosion auto-générative analogue à l’explosion mathématique[2]. Cette mécanique combinatoire est d’emblée entièrement contenue dans un nombre très réduit de conditions structurantes, à la manière dont les suites mathématiques, telle la totalité des nombres entiers et leurs stupéfiantes propriétés, se construisent grâce à trois instructions seulement : point de départ, empan (ou raison), premier terme. On peut conjecturer que nombres irrationnels, nombres univers, nombres premiers et quelques autres classes de nombre (les Zétas notamment) constituent la manifestation phénoménale de ces racines génératives.
Soulignons à nouveau que le passage du rien au quelque chose ne peut qu’être absolument anhistorique, instantané, main-tenant. Il ne peut s’agir d’un récit plongeant de longs bras vers le passé, une sorte de mythe des origines, telle la fable du big-bang. Car le récit du big-bang ne peut se soutenir qu’en présupposant le temps, quand le big-bang est sensé être l’origine de la durée. Sur cette circularité vicieuse, par quoi la conséquence explique la cause, achoppe le dogme scientifique, singulièrement l’incompatibilité entre quantique et relativité, sans plus ni moins de génie que ces traditions nombreuses où il faut l’intervention de quelque divinité ou génie créant le monde depuis l’abri d’une extra-temporalité surnaturelle.
Pour ce qui concerne les échelles fines et primordiales où nous plaçons notre protozoaire expérimental, la durée est pour lui la comparaison entre deux états intérieurs, certains favorables, et fastes, d’autres inconfortables et néfastes. Une telle comparaison n’implique aucune volition, aucun choix. Il s’agit proprement d’une bifurcation passive par laquelle l’animalcule que le hasard a placé dans un lieu défavorable périt, tandis que survit son pareil, environnementalement mieux doté. Survivant, il prorogera la chaîne des conséquences dont il est l’actualisation. Ce hasard favorable inscrit alors l’événement qui le fonde dans la suite des conséquences, dans la suite des possibles futurs. De sorte que lorsqu’il se reproduit, il est déjà comme « anticipé » [3]. Dès lors, on peut parler d’histoire : elle est cette réduction en forme d’entonnoir par quoi le virtuel devient progressivement contingent. Le passé informe le futur à la manière dont l’ADN subsume l’historicité contingente des espèces et la reproduit.
Ainsi s’inscrivent dans le métabolisme de l’animalcule comme au sein des espèces des chaînes de causes et de conséquences immenses et complexes. Quelques ères de complexité plus « tard », des bibliothèques de cas/solutions sont en place : arcs-réflexe, affects, concepts, langues, cultures, qui toutes in fine représentent des solutions énergétiques avantageuses. Pour le sujet nourrissant ces formes au sein des arborescences biologiques qui font de lui un être, il s’agit là de TOUTE la réalité, puisque cette réalité fournit en même temps les cadres de sa propre représentation. Ce n’est pourtant que le feuillage couronnant l’arborescence des bifurcations historiques, dont – à certaines régularités près qu’on nomme lois – la plupart sont contingentes et résultent à chaque fois d’un jet de dé.
[1] Voir notre texte sur la consommation, l’ingestion et la dimension métaphysique du haricot par les populations du Mato Grosso, telles que décrites par Levi Strauss dans « Tristes Tropiques .»
[2] Le principe de « l’explosion numérique » est simple. J’écris ce que je dis : je dis « un », j’écris « un un » soit 11. Me voici avec « deux un » : « 21 ». Je lis « un deux un un ». J’écris « 1211 », etc. Après quelques incréments, l’algorithme forme une chaîne potentiellement infinie d’entiers où se reconnaissent des « suites atomiques » constantes, dont le nombre est comparable à celui des espèces chimiques, environ une centaine, et dont la composition permet de former n’importe quelle chaîne de l’explosion . Voir le GEB de Hofstadter.
[3] Bien que l’Histoire soit toute contenue dans l’instant, rien n’échappe à sa contingence. Pas plus les espèces animales que les représentations structurant leur activité psychique. Si une gigantesque météorite ne s’était abattu au large du Yucatan, peut-être les dinosaures auraient-ils survécu, éteignant dans l’œuf toute possibilité de développement des primates, et avec eux les belles idées que certains d’entre eux, les homo sapiens, conçoivent. Nos idées ainsi ont une histoire, tout aussi contingente, exiguë, corsetée que l’histoire des Empires qui aurait fait des Européens des Asiatique ou des Africains si la fortune des armes n’avait arrêté Gengis Khan ou les Maures.

Rahan et les cocherelles
Quelques ères de complexification « plus tard » nous retrouvons notre animalcule. Les vicissitudes historiques comme sa propre dynamique intrinsèque l’ont fait s’agréger à quelques dizaines de milliards d’autres de ses pareils, agrégation où chacun et tous ont trouvé quelque avantage adaptatif : il est peut-être aujourd’hui un ribosome, un globule rouge, un neurone ou quelque autre cellule confortablement lovée dans les profondeurs de la chair d’un sapiens, disons un chasseur-cueilleur paléolithique.
En l’occurrence, il est une cellule basilaire de l’oreille interne de ce chasseur. La cellule basilaire est dotée d’un fouet sensible à l’agitation affectant le liquide emplissant la cochlée, cette cavité en forme de colimaçon niché au sein de l’os temporal (le rocher). L’humeur qui l’emplit vibre sous l’effet d’un système d’osselets relié au tympan, tympan lui-même mu par les vibrations atmosphériques.
Ce chasseur, nous le surprenons en maraude parcourant à longues enjambées le jardin d’Eden. Dans sa marche, il croise des proies et des prédateurs ; il esquive de multiples risques et dangers : branches qui fouettent, pierres qui chutent, tigres à dents de sabre dont un feulement trahit la présence… Autant de sons, qui selon les mouvements et célérités respectifs du chasseur et de l’objet sonore subissent des glissements par effet Doppler, plus hauts ou plus graves selon que la source et le récepteur se rapprochent ou s’éloignent.
Rahan – c’est le nom de notre chasseur sinon son état-civil – est en quête d’une proie ailée des rémiges de laquelle il compte se composer une parure pour séduire demain, jour du solstice d’été[1], au rassemblement annuel de sa nation une belle Cassandre qu’il convoite. Justement un oiseau venant de droite griffe un pan d’azur encadré de verdure lançant en plein vol une trille. Présage favorable !
Chasseur habile, Rahan décoche sa flèche[2]. Or ce faisant, il met en œuvre, quasi instantanément de formidables capacités de calcul ! Ce qu’effectue dans ce geste le système cognitif de Rahan, sans qu’il en ait conscience, est une comparaison entre un actuel sonore et une bibliothèque de situations analogues, comparaison dont Rahan déduit la vitesse et la direction de sa proie pour ajuster l’angle, la direction et l’impulsion de son tir.
Ce que perçoit d’abord Rahan c’est bien un train d’ondes sonores dont la forme le renseigne sur la célérité et la direction de l’oiseau.
Comment entend notre chasseur ? Ce que son oreille perçoit n’est pas le monde, mais bien via l’oreille interne une maquette du monde, une construction ad novo utilisant le levier du train d’onde incident pour construire dans le milieu liquide de l’oreille un champ d’interférence mimant le monde.
Ouïr c’est apercevoir une figure d’interférence, un hologramme d’instant, qui mime le monde tout en étant le monde, car il ne peut se distinguer entre l’observateur et la mer des phénomènes aucune solution radicale de continuité. Notre chasseur, lui, compare cet hologramme d’instant, c’est à dire la forme du champ sonore perçu, aux chaînes et structures engrammées dans son esprit, collection d’impressions sensorielles, de réponses motrices, d’empreintes visuelles associées. Ces structures engrammées sont elles-mêmes des hologrammes, c’est à dire des nœuds et des ventres, des moirures, des damas, des figures dynamiques évoquées au niveau le plus fin, c’est à dire quantique. Elles ne sont pas passées, mais maintenues, dynamiques, vivantes. Un cerveau mort ne se souvient de rien. Cette bibliothèque de cas est une praxis déposée couche après couche, incrément par incrément, génération après génération par les diverses formes biotiques, de complexité croissante, qui ont précédé le chasseur et dont il hérite. Formes empilées, depuis les plus simples – notre animalcule – jusqu’aux plus sophistiquées – les ancêtres directs de Rahan. Ces solutions préparées d’avance, anticipées, sont la trace d’accidents historiques passés et représentent un formidable avantage adaptatif. Elles s’étendent des formes les plus rustiques – régularités circadiennes résultant du battement dialectique de molécules au sein de la cellule, arcs réflexes – jusqu’aux plus abstraites : art, musique, représentations, structures politiques, cultures.
Tourner la tête dans la bonne direction sous le bon azimut vers un oiseau filant en chantant paraît un geste simple qui pourtant résulte, nous l’avons dit, d’un calcul d’une extrême complexité. Rahan, ou plutôt son appareil cognitif, tant Rahan en tant que personne douée de volition a peu de prise sur le processus, compare à l’échelle quantique des figures d’interférences d’origine interne ou externe où s’isolent et se comparent séries et séries de séries par quoi notre chasseur construit une géométrie spatiale topolagisable permettant l’action. Le niveau fondamental est presque instantané (durée intrinsèque), mais le processus entier de perception/réaction s’inscrit lui dans une certaine durée, de l’ordre de quelques dixièmes de seconde[3].

[1] La Saint Jean
[2] Rahan vit au paléolithique supérieur. Il ne se servirait pas d’arc sinon.
[3] En précisant que toute durée est toujours spécieuse. C’est la durée spécieuse qui contient les plusieurs dixièmes de seconde, et tout le temps : pas l’inverse.
Groupes et nombres
Parler de durée, dès lors qu’elle n’est pas essentielle, pas spécieuse, renvoie implicitement à quelque forme de mémoire et aux lieux où se conserve cette mémoire. Nous avons vu que le simple balancement vibratoire entre harmonie et turbulence pouvait en soi construire une mémoire élémentaire, en ce sens que les champs incidents déterminent l’état interne de l’animal, dont tous ne sont pas favorables. La survie au long de chaînes de générations de notre animalcule manifeste en substance, dans le métabolisme même du protozoaire, cette sorte de mémoire vitale qui favorise les interactions viables et détruit les autres.
L’ADN peut-elle même être conçue comme l’engrammation, sous forme d’un code simple et économe, de chaînes énormes de causes et de conséquences reliant divers états énergétiques, chaînes qui sont constamment actualisées et réinterprétées. Toutefois, nous le notions à l’instant, l’ADN engramme des dimensions beaucoup plus abstraites que la simple activité métabolique de construction/réparation/gestion corporelle.
En effet l’ADN, le patrimoine génétique, reflète l’union d’individus de sexes différents au long de générations multiples. En ce sens, elle reflète également les règles de mariage, ou d’exclusion à l’union dont se sont dotées les cultures. Ces règles, et donc l’ADN qui en est partiellement le produit, renvoient à la totalité des comportements, attitudes et représentations humaines, patrimoniales et économiques, sociales, politiques, culturelles[1].
Toute la physique classique, depuis Platon et sous la puissante impulsion de Descartes, repose sur l’hypothèse qu’il existe, en dehors de toute perception, un monde indépendant et immuable, simple support neutre et anhistorique des phénomènes, des évènements, de la durée, de l’espace.
La relativité et la mécanique quantique ont remis en question la « neutralité » de l’espace et du temps, et posé la question du rapport entre la singularité percevant et l’hors-soi, du phénomène et de l’observateur. Toutefois l’obscurantisme scientiste moderne, butant sur les forces les plus obscures de la nature humaine, refuse de tirer les pleines conséquences, notamment morales et politiques, de l’indissociabilité de « la physique » et « du physique ». De la même manière la médecine a longtemps disséqué des cadavres sur la prémisse que les structures histologiques expliqueraient à elles seules l’homme et sa santé. L’apparition de l’observation « in vivo» érode chaque jour un peu plus la puissance heuristique de tels présupposés.
A l’inverse de ces conceptions occidentales fixistes, l’Orient voit en tout phénomène l’expression d’un flux sous-jacent. L’être n’est que l’apparence de l’action: les états ne sont que des transitions, des passages, les mesures arrêtées d’un flux. Il est possible ainsi que les méridiens de l’acupuncture chinoise ou encore les chakras hindo-bouddhistes ressortissent de systèmes dynamiques, à la fois physiologiquement essentiels, mais sans inscription biologiques tels que le scalpel en pourrait identifier.
Même les entiers naturels n’échappent pas à la temporalité. Le temps est le nombré, affirme Aristote. Car en effet, le nombre est un objet psychique puissamment synthétique et non pas a priori. Les Chinois ont coutume de dire : « Un cheval n’est pas un cheval.» Ils signifient par là que jamais deux haquenées ne sont parfaitement identiques. Pourtant, aucune pensée articulée, aucune reconnaissance du monde ne serait possible s’il ne devait être constitué que de myriades foisonnantes et chaotiques d’objets singuliers.. Ainsi le mot « cheval » est-il une classe d’équivalence où sont reconnues les caractéristiques constantes de l’objet « cheval » et gommées les variations individuelles. Les analogies sont étroites entre la théorie des groupes d’Evariste Gallois et le langage naturel. Peut-être certaines formes d’autismes sont-elles liées à l’impossibilité d’ordonner le monde phénoménal en séries
Le classement analogique par quoi l’esprit identifie des invariants au sein des phénomènes est une condition du dénombrement. Ainsi les nombres figent-ils la réalité changeante, protéiforme et instable au sein d’une perception synthétique reconnaissant la régularité au-delà de la variabilité. Le nombre fixe le flux : il contient déjà la durée, puisque cette durée représente les cohortes de discrimination et la synthèse nécessaires au dégagement d’une notion telle que le « un ». Au surplus et à l’instar du langage naturel, la combinatoire mathématique, tout comme la combinatoire grammaticale ont pour support implicite la durée : il faut un certain temps pour écrire une équation, un certain temps pour la lire. Pareillement, le discours, la lecture ou l’écriture sont des flux de signes qui imposent un substrat implicite que l’on nomme durée, condition de possibilité d’existence même de ce discours, sans qu’en rien il ne soit possible de conclure à la réalité ontologique, essentielle, de cette durée. Pur « util » dirait Heidegger[2].
[1] « Structures élémentaires de la parenté », Levi Strauss
[2] « Util » est le terme proposé par François Vezin comme traduction du terme « Zeug » employé par Heidegger dans Être et temps.

Vortex
Dynamisme et stabilité, flux et forme, course statique d’Alice, autant de figures qui renvoient au vortex comme à l’hologramme dont les dessins, drapés et festons résultent de l’interaction dynamique de deux flux. Le vortex, sous une forme triviale, est le tourbillon, voire le maelström, qui fixe en une spirale convergente le courant d’un ru, d’un fleuve ou de l’océan.
Le vortex manifeste au présent une singularité dynamique stable. Il est à la fois phénomène déterministe et aléatoire, aléatoire dans le sens où les trajectoires individuelles des éléments qui le composent ne peuvent, fondamentalement, être déterminées.
Le vortex est la figure du stable dont le fond est le flux. Il est le stable fondé sur le sable, sur la labilité intrinsèque des phénomènes. Vortex et hologramme sont des figures compatibles en ce sens que l’hologramme est bien la forme stable générée par la rencontre de deux flux de particules ou de photons. L’image même d’un tourbillon est un hologramme produit à la croisée de flux de photons provenant des diverses directions de l’atmosphère (en raison de son albédo), des particules de la masse liquide et enfin du corps de l’observateur, ces deux derniers également conçus comme flux d’énergie.
Le vortex comme figure dynamique permet la représentation du flux sans durée, de l’instant où se love l’éternité. Il permet de se figurer comment la durée spécieuse peut contenir l’espace et le temps. Il permet d’intuitionner ce qu’expérimente Alice qui tombe et se réceptionne sans mal dans ce pays où il faut courir pour rester sur place. Je prétends qu’à rebours de toutes nos croyances sur le temps, la chute immobile d’Alice constitue le fond de nos sensations de la durée.
Nous croyons sentir le contraire, parce que notre entendement nous y pousse : l’instance « entendement » ne peut faire entendre sa voix en nous qu’après que s’est déroulé dans les abysses de l’instant et du cerveau-univers un long et énorme travail d’interprétation et de synthèse. Mais l’entendement nous trompe quand il nous présente les résultats de son analyse comme claires et conscientes. L’imagerie cérébrale in vivo donne chaque jour de nouvelles preuves qu’une large partie de ce que nous croyons être une activité ou une décision conscientes se joue en fait derrière la scène avant la prise de conscience.
Ainsi, à titre d’exemple, le jugement d’une personne envers un visiteur variera selon que le cobaye aura été peu auparavant exposé à un signal subliminal (extrêmement rapide) présentant tantôt un visage souriant ou au contraire revêche du visiteur. Le cobaye croit apprécier le visiteur en toute liberté : mais statistiquement son jugement est corrélé au signal subliminal. La durée se construit dans cette arrière-cour cognitive comme résultat de la pression adaptative, à l’instar du rouge répondant à la nécessité d’identifier les fruits les plus nourrissants.
Le vortex permet de concevoir qu’il faille pédaler pour rester sur place. Le tourbillon dans le ruisseau est en dernière analyse le produit d’un flux d’énergie lié au couple soleil/terre : le premier pompe vapeur et souffle vents, la seconde, massive, tire par gravité l’eau vers la mer. Supprimez ces deux forces, ces deux agents moteurs, il n’y a plus de tourbillon. Supprimez le feu qui nous maintient à 37° C, il n’y a plus ni vie, ni science, ni conscience, ni philosophie, ni big bang. Car individus et espèces sont eux-mêmes des vortex complexes dont l’énergie provient du soleil, bien qu’indirectement via la photosynthèse réalisée par les végétaux ingérés par l’animal, ou par la prédation de proies ayant elles-mêmes consommé de la matière végétale.
Les états du ciron
Les Grecs significativement distinguent dynamisme et énergie. Dire de la vie qu’elle est un état loin de l’équilibre, qu’il lui faut prélever énergie et nutriment, qu’il lui faut excréter, c’est admettre nécessairement que la vie est flux, que tout le perçu est un flux. Il n’y a pas de connaissance statique. Prétendre que les lois physiques sont symétriques par renversement du temps (tX=-tX) est une proposition fausse. Car entre temps, le temps d’écrire cette équation, de la penser ou de la lire, le scripteur, le penseur ou le lecteur ont eux vieilli. La si fameuse et vertigineusement intéressante équation de Wittgenstein A=A est nécessairement fausse : plus exactement elle n’est pas une identité, pas tout à fait une identité, à l’ε près, cet irréductible epsilon partout rencontré, dont l’avatar en physique comme parmi les nombres, probablement se dissimule sous la constante de Planck.
La figure du flux rapprochée de celle la régularité évoque directement celle du vortex. A l’instar du tourbillon dans le ruisseau, le vortex est cette figure qui n’est stable qu’en tant que son fond est dynamique, en mouvement incessant, à la manière dont Alice doit courir pour rester sur place.
On visualise aisément ce qu’est un vortex ou un tourbillon. La si mal nommée théorie du chaos – le chaos ne saurait supporter quelque théorie que ce soit : tout au contraire la théorie expose les relations entre ordre et désordre – a puissamment élargi le concept. Un phénomène complexe où se reconnaissent de multiples trajectoires est susceptible de voir ces trajectoires s’organiser autour de nœuds stables, dits attracteurs étranges, à la manière dont les orbites individuelles des molécules d’eau s’enroulent en tourbillons relativement stables. Ces orbites peuvent-être celles d’objets célestes, ou bien encore décrire l’évolution des espèces vivantes, ou encore celle des colonies d’organismes individuels – bactéries, corail, humains – que l’on nomme sociétés et dont la dynamique dans ce dernier cas porte le nom d’histoire.
Bien que la trajectoire d’une molécule d’eau quelconque traversant le vortex soit fondamentalement indéterminable, la figure et le comportement globaux du vortex le sont[1]. On peut également identifier le vortex, l’attracteur étrange, à un oscillateur stochastique complexe, tel qu’on peut en programmer simplement sur un micro-ordinateur à l’aide d’un jeu d‘instruction très simple, tel qu’en crée le célèbre « jeu de la vie » de Conway qui d’incrément en incrément dessine des configurations stables alors que ne cessent de jouer en arrière plan la dynamique incrémentale. Une corde agitée rythmiquement montre tout autant des ventres mobiles et des nœuds immobiles. Mobilité incessante qui est la condition de la perdurance, tout comme le flux est le fond du stable, tout comme le courant est nécessaire au maintien du tourbillon, ou encore comme est indispensable l’ingestion/excrétion continue d’aliments et d’oxygène au maintien de la vie. L’espèce elle-même est un vortex dont le flux se maintient au long des générations par la naissance et la mort.
[1] Bien que les comportements individuels du bipède humain soient dans leur fourmillement largement imprédictibles, les pulsions qui animent collectivement leurs sociétés le sont, elles, beaucoup plus. On a beaucoup gaussé Ferenczi qui déclara avoir eu la vision d’une mer de feu et de sang peu avant la première guerre mondiale. Pourtant, une telle intuition visionnaire, ou prophétie, n’est-elle pas simplement l’intégration intuitive fulgurante par laquelle l’esprit individuel dépasse ses propres limites et touche au fond des ressorts de l’être collectif ? Les synchronies chères à Jung ne ressortent-elles pas, dans l’ordre symbolique comme physique, de tels comportements massifs ?
Loin de l’équilibre
Etudions désormais de plus près les propriétés d’un vortex tournoyant dans un ruisseau, sans nous interdire la généralisation à d’autres formes de systèmes dynamiques réguliers.
Un tel vortex présente plusieurs niveaux de chiralité. Il peut-être dextrogyre ou sénestrogyre. La force centrifuge y joue, mais également la force centripète, dès lors que notre vortex s’inscrit dans un champ de gravité. Combinées ces forces trient différentiellement, selon, leur taille et leur densité les éléments inscrits dans le flux, rapprochant ou au contraire éloignant telle ou telle espèce chimique ou variété biotique, favorisant ou au contraire entravant certaines réactions, certains agrégats.
Ainsi le vortex crée-il de l’ordre, concentre l’énergie dispersée du milieu et renforce – jusqu’à un certain point – sa propre stabilité. Stabilité qui en retour favorise l’émergence de structures de plus en plus complexes dans une boucle potentiellement infiniment rétroagie.
Notre animalcule, entité loin de l’équilibre, à l’inverse du rocher inerte, échange intensément avec son milieu. Les excrétions comptent au nombre de ces échanges. Or parmi ces produits d’excrétions, certains au cours de l’évolution ont renforcé des boucles de rétroaction avantageuse pour l’excréteur, individu isolé ou population. Les autres, défavorables, n’ont pas subsisté et ne sont pas là sous nos yeux pour nous contredire. Dès lors qu’ils favorisent la population excrétrice, ces « excréments » se construisent en milieu, potentialisant encore la boucle de rétroaction positive. Ainsi l’oxygène est-il un produit de dégradation biotique. Ainsi l’humus peut-il être considéré comme l’excrétion des milliards de tonnes de bactéries, animalcules, champignons, végétaux qui peuplent le sol, leurs cadavres mêmes étant des produits d’excrétion de la vie confrontée à la double nécessité de se débarrasser des machines usées pour en assembler de nouvelles.
Nombre de bactéries produisent une sorte de glaire protectrice. Elle est d’autant plus protectrice que la masse excrétée ou exsudée est importante, et donc la population productrice importante, dans une boucle rétroagie positivement – la population croit – jusqu’au point climax où sa taille épuise les nutriments disponibles. L’exosquelette corallien agglutiné en récifs entiers en est un exemple. Les populations vivantes ont cette capacité de prolonger hors-soi quelque chose de l’en-soi qui détermine localement un artefact, un milieu extérieur favorable. Dans les populations humaines, ces « glaires » se nomment « villes », « maison », « territoire », « représentations », « culture ». Ces représentations et cultures, au mitan de l’en soi et de l’hors-soi, ont proprement valeur adaptative. Des cultures sont mortes de structures politiques ou sociales inadéquates[1]. La diversité est un remède[2] : si l’hétérogénéité règne au sein d’un groupe (de bactéries ou de nations), elles ne seront pas toutes également affectées par un brusque aléa environnemental, une épidémie, un retournement économique, un changement politique. La physique, depuis toujours, est politique. Singularités pérennes loin de l’équilibre, les populations vivantes (populations de micro-organismes, population de cellules, populations de macro-organismes complexes) suscitent des flux de matière et d’énergie à l’origine de méta formes stables, films de cyanobactéries, stromatolithes, récifs coraliens, organes, espèces, sociétés, malgré la disparition constante des unités qui les composent et grâce à la génération de copies nouvelles.
Etre ici maintenant revient donc à actualiser constamment des chaînes énormes d’évènements. Le vortex est l’une des figures de cette actualisation. Il inscrit la figure stable dans le mouvement. Il induit une chiralité, celle notamment où la masse assemblée des éléments – atomes colligés en molécules, cellules réunies en organes et organismes, individus associés en sociétés – leur confère en tant que « vortex collectif » plus de stabilité qu’à la collection d’unités isolées.

L’organite le plus simple vibre en quasi-conjonction avec le champ extérieur dont il subit presque directement les agressions. Il est ainsi très vulnérable : les rayons cosmique fracturent ses molécules, les ultra-violets le brûlent, le sel l’attaque. Il maintient difficilement son homéostasie. Modifier le milieu encaissant pour le rendre plus propice à la survie de la singularité est l’une des solutions favorables à la vie[3]. Elle est d’autant plus efficace que cette modification du milieu est le fait d’une population plutôt que d’un individu isolé. Une population d’organites, une colonie de bactéries, un récif corallien, une collection de cellules assemblée en organisme, des individus réunis en société, se voient conférés une stabilité personnelle et collective accrue.
C’est ainsi que notre organite, celui dont nous suivons les aléas ontologiques, est devenu cellule basilaire nichée au sein de l’oreille interne de Rahan, notre chasseur-cueilleur. Pour notre organite, le corps de Rahan, représente un avantage adaptatif, tout comme pour Rahan, à une échelle supérieure, sa propre famille, sa propre nation, sont gage de sécurité et de stabilité.
[1] Jarred Diamond , « Effondrement »
[2] Jacques Monod ,« Hasard et nécessité »
[3] La logique symbiotique s’étend au domaine intracellulaire même : ainsi, il se pourrait que le ribosome soit un organite archaïque infiltré au sein de la cellule, où il aurait trouvé un environnement favorable et à laquelle en retour il fournit de l’énergie.
Le crible des sens
Il y a toutefois un revers à cette médaille. Si l’organisme collectif massif réalise plus aisément son homéostasie que le protozoaire isolé, la masse même de l’organisme complexe en isole les parties internes des influences externes. Ces dernières sont à la fois périlleuses – un amphibien exposé au soleil sur un terrain sec loin d’un milieu humide ne tarde pas à périr – et en même temps bénéfiques quand elles signalent les sources de nourriture ou le partenaire reproductif vers lequel il faudra se diriger pour se pérenniser.
Protégées des influences délétères venues de l’extérieur, les cellules internes se trouvent dans l’organisme massif sourdes aux signaux qui leur permettaient lorsqu’elles étaient isolées une adaptation adéquate et rapide aux conditions changeantes du milieu externe. Surdité qui peut mettre en danger l’intégrité du collectif-corps.
Seuls se maintiennent alors les collectifs-corps capables de profiter des avantages de la grégarisme tout en maintenant une relation, même indirecte, entre l’extérieur et les individus-cellules logés dans les feuillets les plus profonds de l’égrégore. Si ces organismes massifs ont survécu, c’est qu’ils ont maintenu, au-delà de leur agrégation, quelque possibilité de relation avec l’extérieur. Pour le dire simplement, ils développé des instances leur permettant, malgré leur masse et l’isolement de leurs parties internes, quelque moyen de conserver une relation avec les influences extérieures, tant avantageuses que périlleuses : autrement dit des organes du sens.
Remarquons ici que notre organite devenu cellule basilaire reste un individu aquatique. La cellule basilaire vit et meurt en effet dans le liquide cochléaire dont est emplie l’oreille interne. Elle partage ce statut avec l’intégralité des cellules de l’organisme supérieur qu’elles composent, en l’espèce, Rahan. La peau, au contact de l’air, l’épiderme, est composée de squames, c’est à dire de cellules mortes, tandis, tandis que le derme sous jacent dont les squames sont le cadavre, demeure lui pleinement irrigué. L’animal, même très complexe, même aérien, reste avant tout un poisson, un animal liquide, une bulle roulant sur la terre ferme et sèche.
L’audition, dont la première instance est la vibration de l’organite en réaction aux ondes de pression parcourant le fluide dont le corps est baigné, l’audition donc reste un sens aquatique malgré l’énorme complexification qui nous amène aux animaux supérieurs dotés d’organes des sens adéquats. La cochlée est ce qu’il reste en nous du poisson archaïque que fut notre organite. Ce liquide logé dans une cavité en forme de colimaçon vibre sous l’impulsion d’un diaphragme solidaire d’osselets eux-mêmes mécaniquement liés au tympan externe et suscitant des ondes de pression stimulant le tapis des cils basilaires disposé en trapèze épointé.
Colimaçon liquide, champ de cellules basilaires disposées géométriquement en rangées, en perspectives, voici les bases de l’interprétation sonore du monde. Voilà la géométrie essentielle de notre audition, qui ne saurait être étrangère à la géométrie intrinsèque du monde – une même matière constitue à la fois l’univers et l’animal – sans se confondre totalement avec elle, sauf à ne pas être comme entité distincte. C’est au travers d’une transformation mimétique du monde, d’un type mathématique d’une inimaginable complexité, que nous nous représentons le monde. Et c’est dans le procès de cette transformation que se créent les catégories de l’espace et du temps.
Le nombre de cellules basilaires est restreint : quelques dizaines de milliers. Si les écrans de nos ordinateurs devaient n’avoir qu’une définition aussi grossière, nous nous plaindrions des pixels nuisant à la compréhension de l’image. Or notre expérience n’est pas celle d’un monde disjoint, d’un monde discontinu. Tout au contraire.
La même remarque vaut pour la vision. Bien que les longueurs d’onde se répartissent sur un continuum, notre rétine polarise ce continuum autour de trois types de cellules, sensibles seulement au rouge, au bleu, au vert. Malgré un faible nombre de récepteurs, malgré une tache aveugle au point d’insertion du nerf optique, empli ultérieurement par le cerveau d’une image fictive, nous n’avons pas du monde une perception tachiste ou pointilliste, mais au contraire continue. Nous n’entrerons pas ici plus avant dans le détail du procès par quoi l’organe cognitif interprète le monde, sinon pour noter que le cognos applique (au sens mathématique) le volume tridimensionnel du monde sur deux rétines, surfaces courbes (riemanniennes) en deux dimensions tapissant les globes oculaires, dont les signaux coalescent et se distribuent ensuite via le chiasme optique pour se projeter sur diverses instances limbiques ou corticales, dont chacune interprète la bouffée des influx pour finalement projeter sur l’entendement une image crédible du monde. Crédible seulement, mais non pas réelle, dans le sens où l’objet extérieur reste à jamais inaccessible, mais seulement re-présenté.
On sait ainsi que le mouvement rapide – la trajectoire d’une balle de tennis, par exemple – n’est jamais perçu, sa vitesse excédant la persistance rétinienne. Son mouvement, sa trajectoire, sont déduits, non pas perçus. De la même manière, quoi qu’on y fasse ou veuille, nous ne pouvons voir nos yeux bouger, lorsque par exemple nous tournons le regard vers quelque objet nouveau de notre curiosité. La vitesse angulaire de ce mouvement est trop rapide pour qu’en son cours nous saisissions quelque image que ce soit du phénomène extérieur. Or mis bout à bout, ces déplacements oculaires représentent tous les jours plusieurs minutes. Nous sommes aveugles une partie de notre temps sans nous en rendre compte ! L’esprit remplit les trous d’une image crédible bien que parfaitement illusoire. Nous n’avons pas plus conscience de notre macula, ce point d’insertion du nerf optique sur la rétine, dénué de cônes ou bâtonnets, et donc aveugle. Confronté au phénomène, par interpolation, l’esprit emplit d’une image fictive mais crédible – statistiquement prédictible au regard de la bibliothèque des cas probables engrammés.
Les cafards, pareillement, seraient aveugles lors de leur déplacement. D’où leur étrange comportement où se succède par saccade courses rectilignes échevelées et arrêts. Lors de ces arrêts l’insecte prendrait connaissance de son environnement et de ses dangers potentiels – notamment le balai qui cherche à l’écraser – pour décider d’une direction où fuir pour une nouvelle cavalcade suivie d’un nouvel arrêt et ainsi de suite.
C’est en ce sens que certains cogniticiens considèrent que nous ne voyons pas à proprement parler le mouvement, mais au contraire des captures instantanées que nous relions ensuite par du « mouvement peint sur une toile fixe ». La géométrie de ces transformations est celle là même de notre perception. Elle est pour nous de l’ordre de l’évidence, du percept, de l’intuition sensible. Aussi sa description au niveaux les plus intimes restera-t-elle probablement à jamais hors d’atteinte. Car en effet, vient un stade dans la régression logique où le mouvement fondamental du discours, nécessairement sous-terrain et inconscient, s’identifie au mouvement du processus que le langage décrit.

La mer des moires
Comment un nombre limité de cellules basilaires, comment trois types de cellules sensibles seulement au rouge, au bleu, au vert, comment une collection discrète d’influx peut-elle construire une représentation continue ?
Pour ce qui concerne l’audition, une possible explication tient à la forme particulière du tapis de cellules basilaires. Elles ne sont pas disposées au hasard mais en un champ où se dessinent des rangées et des quinconces. Cette disposition particulière rend possible à la fois l’analyse et la synthèse des flux. La transformation de Fourrier indique qu’il est toujours possible de décomposer un train d’ondes complexe en diverses composantes discrètes. C’est ce que permet la disposition particulière du tapis basilaire. Chaque cil vibratile est agité en reflet à l’agitation du monde. La collection de toutes informations parcellaires et discrètes recueillies par chacun et tous de ces fouets vibratiles est ensuite reglobalisée par une opération inverse à la décomposition de Fourier par les instances cérébrales supérieures en une image plausible du monde.
La disposition en quinconce du tapis basilaire évoque la figure l’hologramme[1]. La quinconce en effet, sous quelque angle qu’on la considère, présente des alignements, à la manière dont l’hologramme, aperçu depuis n’importe lequel de ses points renvoie à sa propre totalité.
Un hologramme, on le sait, est la figure d’interférence construite au croisement de champs d’ondes incidents. Dans sa version photographique (c’est à dire tridimensionnelle), un objet est photographié sous divers angles. Ces clichés sont ensuite projetés dans l’espace. A la croisée des divers trains d’onde incidents se forment alors une série de figures d’interférence reproduisant l’objet original. On généralise aisément en esprit l’hologramme tridimensionnel dans l’hyper-espace n-dimensionnel. Bien que l’interférence ait un lieu, elle manifeste l’ensemble du champ d’interférence, comme le fait l’hologramme photographique, qui en quelque point et sous quelque angle qu’on le scrute contient l’intégralité de l’information relative à l’objet photographié . Autrement dit, l’hologramme reproduit même les portions de l’objet cachées à l’œil, tout comme la molécule d’eau de l’océan intègre à chaque instant l’ensemble des mouvements et des forces affectant la masse amère.
L’interférence holographique à la croisée de champs vibrants est la forme générale de tous les phénomènes, s’il est vrai que toute matière est également figure ondulatoire à la croisée d’autres champs vibratoire, s’il faut admettre électromagnétisme, quantique et leurs outils mathématiques. L’univers entier serait alors de nature holographique. L’hypothèse en effet permet de penser l’incroyable diversité des phénomènes et leur complexité comme la croisée de réverbérations multiples depuis une source simple, à la manière dont dans une baie marine la houle se diffracte en touchant le rivage en une multitude de systèmes d’ondelettes, formant à toutes les échelles – celle de la jetée et du môle comme celle du grain de sable à la rive – des figures dynamiques et chatoyantes[2].
L’hypothèse de l’hologramme permet également de comprendre comment à partir de signaux fragmen,taires et discontinus les sens peuvent construire une réplique plausible et continue de l’univers. Plausible seulement, c’est à dire conforme à l’expérience adaptative, car il n’y a pas de physique en soi, pas d’être en soi, pas d’univers en soi, pas d’espace ou de durée en soi, mais seulement une trans-formation dynamique toujours renaissante.
Notre ciron expérimental est un organite des plus simples : quelques chaînes protéiques agglutinées, pas nécessairement de membrane. Originellement aquatique et isolé – par hypothèse – notre protozoaire possède une ouïe très fine, puisque la moindre onde de pression le traverse de part en part presque sans inertie. A mesure qu’il se complexifie, qu’il devient morula, colonie de cellules, colonies d’attracteurs étranges, groupe de vortex, les régimes vibratoires induits dans son corps et par quoi il « entend » le monde, ces régimes tendent à s’écarter, à différer, à s’autonomiser par rapport aux rayonnements incidents.
Toutefois, un animal complexe et massif comme nous le sommes maintient une certaine capacité à percevoir les ondes de pression autrement que par les oreilles, c’est à dire par la peau, par l’os, voir par les viscères dès que ces ondes sont suffisamment puissantes. L’on sait également que l’ont « voit » par la peau [3], les cellules de l’œil n’en étant probablement que des éléments spécialisés au cours de l’évolution. Il existe ainsi plausiblement un vaste pan de notre relation sensuelle au monde dont nous n’avons pas conscience bien que son statut soit celui de la partie immergé de l’iceberg.
Entendre par la peau, entendre via notre enveloppe, n’est pas si infréquent : les tambours et les baffles surpuissantes qu’affectionnent les rêveurs «raveurs» ressortissent de ce type d’audition de type archaïque, enveloppante et profonde, à l’instar de ce que fut la sensation primordiale du son pour l’organite dont le corps entier baigne dans le fluide sonore.
Caractère archaïque rendant compte peut-être de sa puissance évocatrice et de sa capacité à susciter cet état de conscience particulier que l’on nomme transe ou qui tout simplement fait s’agiter les gambettes sous nous, et comme par devers nous, que suscite une mélodie au rythme particulièrement dansant.
La vibration synchrone du corps de l’animalcule en relation avec les champs incidents s’assimile, nous l’avons vu, à une forme primitive de capacité calculatoire ou logique, dans le sens où la synchronie – l’octave – représente probablement pour le protozoaire un régime « confortable » tandis que les régimes dysharmoniques conduiraient à des états turbulents, dissipatifs, biologiquement moins favorables, moins confortables. Cette alternance d’états plus ou moins propices au travers desquels l’animal « recherche » l’optimum énergétique entre entropie et néguentropie, se dessine en filigrane, croyons-nous, la durée. Cette durée, qui est comparaison, d’abord instantanée et directe entre les diverses phases dynamiques que traverse l’animal en réponse à l’agitation périodique du milieu externe, s’engramme dès la troisième bifurcation dans le métabolisme.
[1] David Bohm, “ Wholeness and the Implicate Order.”
[2] Voir sur cette question les travaux de Jean-Pierre Luminet
[3] La luminothérapie soigne ainsi les dépressions hivernales notamment en éclairant l’aisselle du genou

Troisième bifurcation
Précisons ici ce que peut bien signifier « troisième bifurcation » dans la sorte de symplectique que nous construisons. La première bifurcation est ce par quoi quelque chose existe plutôt que rien : celle-là est à jamais hors de portée de l’analyse, puisqu’elle en est la condition de possibilité. Elle est l’équivalent de l’insaisissable instant zéro de la théorie du big bang. La seconde concerne la possibilité de comparer l’état présent contre le fond de l’état initial, même donné par défaut a priori et à jamais inaccessible. Pour prolonger l’analogie avec le big bang, nous sommes ici sur l’enveloppe (ou horizon) de Planck. La troisième concerne la mémoire, c’est à dire la comparaison entre l’état second et son moment successeur. Nous sommes dès lors en pleine historicité. Dès lors, l’état antérieur s’exprime comme conservation du moment dynamique de l’animalcule, dont l’état réel ne s’ajuste qu’avec inertie aux conditions extérieures: cette conservation amortie du moment, ce décalage est déjà une mémoire. A mesure que cette capacité s’incorpore dans des instances de plus en plus complexe, la distance croit entre le stimulus extérieur brut et son interprétations cognitive, de plus en plus amortie, assourdie, filtrée, interprétée. L’une des dimensions de cet amortissement ou de ce filtrage est la durée.
Comment l’ouïe a-t-elle pu se construire ? Si l’animal est unicellulaire et que son milieu est liquide, l’animal en son entier, enveloppe et intérieur, est une oreille. Il est un oscillateur vibrant globalement en réaction avec le champ incident.
Dès que bactéries, protozoaires, cellules s’organisent en colonies de plus en plus massives, puis en organismes multicellulaires complexes, l’exposition de l’organite aux champs incidents n’est plus directe mais médiate. Enfoui dans la masse du corps, à l’abri des rayonnements directs et périlleux de son environnent, l’organite n’est plus qu’en relation lointaine avec l’environnement. S’abriter au sein du corps collectif représente donc à la fois un avantage et un risque. Avantage dans la mesure où l’organite est protégé des influences extérieures destructives : alternance du chaud et du froid, rayonnements ionisants, bombardement cosmique, etc. Risque, dans le sens où coupé des influences extérieures, l’organite n’a pas la possibilité de réagir rapidement aux changement des conditions externes. D’évidence, plus l’animal est massif, plus le rapport du nombre des cellules périphériques exposées vers l’extérieur à celui des cellules à l’abri de ces influences extérieur est important. S’il ne maintient pas quelque possibilité de relation avec l’extérieur, l’animal complexe met alors en péril sa survie.
Outre une protection mécanique accrue, la massification accroît également l’homéostasie de l’animal complexe. Mais la massification est également une menace si la colonie – le corps complexe – n’a pas construit quelque organe de relation sophistiqué permettant aux cellules profondes de réagir aux perturbations extérieures, avec lesquelles elles n’entretiennent plus de relations directes.
L’organisme doit donc maintenir quelque instance permettant la rétroaction interne en réponse aux changements des conditions externes. Ces instances sont la peau, la rétine, l’oreille, l’odorat, la vue, le toucher, les sensations proprioceptives[1], l’entendement qui les agrège et les synthétise.
[1] On distingue traditionnellement cinq sens. La tradition védique y ajoute l’esprit, considérant qu’il possède un rôle actif dans la construction de la représentation du monde. Depuis quelques années, la collectivité scientifique considère qu’on doit ajouter aux traditionnels cinq sens de nombreux systèmes nous renseignant sur notre position dans l’espace ou encore sur la position des segments de nos membres, etc
Sens et chiralité
Comment toutefois penser l’organisation sophistiquée des organes des sens en refusant toute téléologie, tout plan, tout dessein, tout programme ? Il suffit de reconnaître que se maintiennent toujours actuelles, à tous les niveaux de complexité, des forces, des constantes, des régularités. Il n’est d’ailleurs pas certain que ces constantes, régularités, chiralités soient d’emblée nécessaires. Peut-être ne sont-elles que contingentes, résultant d’un premier jet de dé parfaitement aléatoire mais qui ensuite fixe irréfragablement la suite des conséquences dans le sens décidé par ce premier coup.
Les chiralités sont fort nombreuses autour de nous. Le terme dérive du grec chiros, main, comme dans chiromancienne et réfère au fait que tous les humains sont latéralisés, la plupart droitiers, quelques uns gauchers. La même chose vaut pour l’enroulement des coquilles des colimaçons, où l’un des ses est massivement préféré à l’autre. L’univers quant à lui est composé de matière, plutôt que d’antimatière, quand la théorie prédit que les deux espèces ont été produites en quantité égales. L’univers aurait-il pu être radicalement différent.
De manière analogue, tout le vivant est constitué de molécules dextrogyres (elles dévient la lumière polarisée vers la droite), respectant toute cette chiralité initiale qui une fois le jet de dé initial posé [1], une fois le hasard épuisé, devient nécessité.
Le photon lui-même est asymétrique; il vire sur lui-même (il est doté d’un spin (il tourne sur lui même dans une direction). L’étude a montré comment le rayonnement solaire tombant sur une mare saturée de molécules prébiotoques aurait favorisé une classe de molécules chirales plutôt que son miroir symétrique, déterminant ainsi une partition du monde dans laquelle seule une famille de molécules soutient la vie tandis la famille miroir, elle, devenait toxique.
Le prion, responsable croit-on de l’encéphalite spongiforme, est un pathogène lévogyre, tandis que sa forme miroir, elle, est inoffensive. Ces asymétries auraient favorisé certaines réactions chimiques plutôt que d’autres et de fil en aiguille rangé le monde dans l’ordre que nous lui connaissons. Cette chiralité initiale se recompose à toutes les échelles, depuis celle affectant la particule fondamentale jusqu’au corps humain, symétrique dehors mais asymétrique en profondeur, et jusqu’aux sociétés humaines, dont Lévi Strauss a montré qu’elles avaient une tendance générale à la division en clans, lignées, castes, catégories. Le même Lévi Strauss montre également qu’aucune connaissance n’est possible, qu’aucune culture ne peut se construire sans poser à l’origine une distinction permettant la classification. Fût-elle parfaitement artificieuse – comme de distinguer parmi les choses celles qui sont jaunes de celles qui ne le sont pas – cette distinction arbitraire possède une efficace. Ainsi étonnamment, une pharmacopée fondée sur ce critère arbitraire – être ou non jaune – , une telle pharmacopée soigne [2]. Peut-être la tendance au bipartisme des « démocraties » complexes occidentales ressortit-elle également de cette tendance fondamentale. Il est douteux d’ailleurs que la rationalité scientifique à prétention universelle ne se fonde, elle non plus, à quelque niveau, sur une forme d’a priori cognitif inconscient de type métaphysique. Or comme la science ne saurait, par hypothèse implicite, être métaphysique, elle construit ainsi ipso-facto un système clos, auto-référentiel, ou dirait Popper, irréfutable. En d’autres termes, la science est naturelle, comme Pharaon ou Louis Capet n°14 étaient fils du Soleil. Circulez, y a rien à voir…
Laissons ici cet aparté , pour en revenir aux chiralités, ces pressions formatrices constamment jouées et rejouées au présent, qui rendent compte de l’émergence et de la persistance des structures sensibles de relation.
Nul besoin d’invoquer d’autres pressions morphologiques autres que ces quelques chiralités simples, mais toujours exprimées d’emblée, incrémentées à chaque niveau de complexification, un peu comme les forces atomiques jouant au niveau de la glace contiennent en puissance les formes étonnantes du flocon de neige. Ces chiralités sont toujours en jeu au présent, achroniques, à la racine même de tout phénomène.
[1] La figure du jet de dé parcourt le Mahâbhârata de part en part. C’est aux dés que le sort des batailles se joue. C’est au dé que les dieux donnent une nouvelle impulsion à l’univers quand il a épuisé les virtualités du coup précédent.
[2] Levi Strauss : La pensée magique
L’histoire du hasard
La cellule basilaire reste un organite très simple. Avec d’autres, elle a « construit » une colonie massive dont la masse même est garantie d’homéostasie. Homéostasie de masse avantageuse du point de vue de la cellule isolée ou de la colonie restreinte, mais qu’elle prive au-delà d’un certain de possibilité de réaction aux changements du milieu, constituant dès lors en cela une menace.
La cellule basilaire ignore totalement représenter une porte d’entrée pour des signaux provenant de l’extérieur. De « son » point de vue, elle est un organite quelconque jouissant d’un environnement favorable, en l’occurrence un corps. Ce corps, cette colonie de cellules, n’aurait lui-même pu se maintenir vivant, via les générations successives, s’il n’avait conservé la capacité intrinsèque à l’organite isolé à réagir à son environnement. Les sens et leurs organes prorogent donc au sein de l’animal complexe cette capacité inhérente à l’animalcule d’adopter tel ou tel régime vibratoire en réponse aux influences incidentes. D’incrément en incrément, la cellule basilaire prolonge cette aptitude essentielle, déjà présente aux niveaux les plus élémentaires, mais cette fois exprimée au sein d’un corps complexe. Et c’est parce qu’un telle capacité est fondamentalement nécessaire que se sont maintenues au sein du corps complexe des sous-populations de cellules capables de le renseigner sur le monde extérieur. La sélection naturelle a sélectionné positivement les cellules basilaires, les cônes, les bâtonnets, bref les structures de relation, sans quoi le corps complexe lui-même serait vite balayé.
La cochlée n’a pas foré a posteriori le rocher pour se rapprocher des centres d’intégration supérieurs. Elle ne s’est pas formée dans le rochée. Rocher, cochlée, nerfs, structures limbiques ou corticales ont co-évolué de manière si intriquée qu’il n’est pas au fond possible de distinguer leur forme du sens qu’elles génèrent.
Dès qu’il s’individualise, l’organite est confronté aux lois de la thermodynamique, qui lui imposent de prélever dans son milieu l’énergie nécessaire au renouvellement constant de sa structure propre. Or ce même indispensable prélèvement énergétique, qui place l’animal loin de l’équilibre, représente un risque. Mal régulé, il peut conduire à la mort de l’animal (ainsi une fièvre trop élevée tue). C’est précisément grâce aux organes des sens que cette régulation fine est possible. Et c’est parce qu’il s’agit d’une nécessité impérieuse constamment rejouée que s’est maintenue la capacité fondamentale de l’organite à réagir à son milieu, sous l’espèce d’organes sensibles complexes, mais dont la complexité prolonge directement la réactivité primitive de l’organite.
Nul besoin d’invoquer quelque dieu à barbe argentée ou quelque « dessein intelligent » pour rendre compte de la complexité des organes des sens. Il suffit de constater qu’à tous les niveaux de complexification, à chaque incrément, à chaque sophistication jouent toujours les mêmes forces, les mêmes chiralités. L’ouïe ne s’est pas construite grâce à quelque mouvement de complexification, elle s’est maintenue au travers de la complexification
La cellule basilaire n’a jamais ou l’intention ou le projet de bâtir quoi que ce soit. Il est très difficile, tout spécialement en Français, d’exprimer une action sans la doter d’un sujet. Or, ce nécessaire sujet grammatical implique d’emblée une forme de téléologie et impose des propositions telles que: « c’est parce qu’elle l’a décidé que la cellule basilaire s’est associée à d’autres », ce qui est évidemment absurde. Le langage est ainsi tout imprégné de téléologie, de telle sorte qu’il tend à chaque pas des chausse-trappes logiques obscurcissant le monde. La puissance heuristique du discours naturel, et je compte les mathématiques au nombre des discours naturels[1], est ainsi limitée, voire négative, à l’instar de l’ornière où tombe et retombe la roue.
La durée intrinsèque du discours est son biais le plus rédhibitoire. Le théorème est toujours faux. L’équation d’identité A = A[2] est fausse, car il y a bien deux « A » différents, tant dans le lieu que dans la durée (je dis ou lis le « A » de gauche avant le « A » de droite). L’identité (=) n’est qu’à peu près. Si A=A, alors autant écrire A. Mais alors on s’interdit toute comparaison, tout recul, toute connaissance. Une histoire est toujours fausse, toujours après coup, toujours déjà dans la durée spécieuse, avant le prochain coup de dé. C’est la limite de la logique, la limite de tout discours formel, la limite de l’axiomatique, comme l’a montré Gödel.
[1] Voir sur ce point cet ouvrage fondamental qu’est le GEB (Gödel, Escher, Bach) de Douglas Hofstadter
[2] Wittgenstein : Tractus logico-philosophicus

Mémoire et hasard
Comment l’histoire peut-elle être avant le prochain coup de dé ? Elle l’est nécessairement car toute située dans la durée spécieuse, qui pour quasi instantanée qu’elle nous apparaisse relève pourtant d’une construction déjà extrêmement sophistiquée. Elle s’exprime comme anticipation projetée loin dans le futur, comme « mémoire » annonçant l’état prochain. Mais ce futur est toujours une anticipation interne au présent, un réceptacle tout préparé pour le prochain coup de dé. J’ai procrée des enfants qui me succèdent, que j’anticipe sans pourtant que cesse en aucune manière le jeu du hasard. Les dieux hindouistes relancent l’univers épuisé en lançant les dés.
Il est facile d’anticiper les valeurs rendues par un jet de dé. L’ensemble des phases du jeu de dé est parfaitement déterminé – {1 ;2 ;3 ;4 ;5 ;6} – bien que chaque lancé soit inanticipable.
Il n’est pas si aisé d’anticiper notre futur, à quoi ressemblera le nouveau-né et quel sera son caractère. Pourtant l’un et l’autre de ces hasards présentent un degré d’ordre : ils sont stochastiques.
Dès que deux états internes se succèdent en réaction aux pressions extérieures, une forme de mémoire apparaît, liée d’abord à l’inertie de la réaction du corps singulier par rapport à, la dynamique de son environnement. Cette inertie différentielle constitue un embryon de mémoire. Cette « mémoire » peut tout simplement s’exprimer par la disparition de l’animalcule et de sa lignée, tandis qu’une lignée un peu différente et mieux à même de surmonter l’agression extérieure survivra et se prolongera. Dans ce sens la survie de cette seconde espèce constitue elle aussi une forme de mémoire. Mais en se complexifiant, en se massifiant, l’organite complexifié peut voir apparaître des instances particulières conservant la trace des évènements passés – c’est à dire devenant passé à mesure qu’ils s’engramment. Ces instances conservent et amplifient la réaction inertielle initiale, purement passive. L’engrammation présente contient le passé. Elle n’en est pas le produit, mais au contraire le produit.
Tout simplement parce qu’il est avantageux de jeter sur le prochain coup de dé le crible du possible : le futur admet dès lors un domaine possible, un autre improbable. Puis l’impossible survient, inscrivant une nouvelle trajectoire de conséquences, un nouveau réel possible, anticipable. L’événement, qui actualise et discrimine le possible, apparaît alors comme conséquence d’une cause qui semble l’anticiper. Mais cette cause n’est que l’avatar d’une chaîne de conséquences que l’événement actualise, manifeste. Je ne suis pas la cause de mes enfants, pas plus qu’ils ne sont mes conséquences. Il y a de fortes raisons de penser que nombre des actes par lesquels nous croyons agir librement ne sont que des conséquences de trajectoires que nous ne faisons qu’actualiser, sans que soit mis en mouvement un quelconque libre arbitre. Et si nous croyons en conscience poser un acte libre[1], encore faut-il suspecter la conscience de nous tromper. A titre d’exemple, si l’on présente à un cobaye humain, de manière subliminale la photographie du visage souriant, ou au contraire grimaçant, d’une personne qui entre l’instant suivant entre dans la pièce où se déroule l’expérience, le cobaye la trouvera sympathique ou non, selon que le portrait présenté furtivement était avenant ou non. « Je est un autre », disait Rimbaud dans sa clairvoyante folie.
Seul le présent donne pour vraie la relation de la cause et de la conséquence, sans que l’une précède l’autre. C’est bien plutôt l’actualisation présente qui est la cause du passé en manifestant des trajectoires acquises. Ma représentation me les présente comme antérieures, et donc causes, quand elles ne sont que rémanence actuelle dans la durée spécieuse.
Le passé est une proposition fausse. Le passé comme forme anticipée d’une actualisation imminente[2], voilà qui me paraît plus juste et plus conforme à mon sentiment intérieur. Les dinosaures ont existé, mais au présent !
[1] L’accent porté sur le lancé de dé nous met à l’abri de l’accusation de tomber dans un déterminisme de comptoir. Nous croyons à la possibilité du libre arbitre et de la conscience. Mais nous croyons que les ailes d’Icare et prométhéisme humains doivent être sérieusement rognés et avec elles les philosophies politiques et sociales fondées sur le libre arbitre et la décision constante. Si nous ne réussissons pas dans cette entreprise, la catastrophe globale en vue à l’horizon s’en chargera bientôt.
on insiste suffisamment sur le lancé de dé pour qu’on nous aIl n’est pas question de tomber dans un déterminisme de comptoir du type « tout est déjà écrit »
[2] Certaines expériences quantiques, contre tout sens commun, semblent indiquer que l’interaction instantanée informe le futur, comme il semble aller de soi, mais également le passé : c’est dans le monde de la logique décohérée proprement stupéfiant.

Troublant trou noir
La durée spécieuse n’est pas une idée de philosophe. Ce n’est pas une simple figure de rêve, une girafe volante[1] comme l’esprit en fantasme à foison. C’est une intuition directe, triviale, générale, commune et tellement évidente qu’elle est comme l’air transparent et qui n’existait pas avant que Torricelli l’invente. Mais le poisson humain n’a pas encore compris qu’il vit dans l’eau.
Ce que pourrait être cette durée spécieuse et « combien de temps elle durerait », l’observation expérimentale nous en donne quelques indices. Sa forme fera l’objet d’études futures, intéressant tant la physique théorique et expérimentale que les théories de la connaissance, avec l’aide singulièrement pertinente des techniques d’imagerie in vivo. Mais on en connaît certains jalons : entre le moment où le feu passe au rouge et le moment où je perçois le changement de couleur, une bonne demi-seconde s’est écoulée. Les niveaux les plus fins de l’activité cérébrale reposent sur des niveaux où l’attoseconde bât la cadence (10-18 s.). Si nous dilations ce tempo, de manière que chaque oscillation du métronome dure une seconde, nos vies dureraient des milliards d’années et les secondes de notre quotidien s’étaleraient elles sur des millions de circambulations géosolaires. Ainsi la durée spécieuse contient-elle des myriades de myriades d’instants élémentaires non encore parvenus chacun à la durée tout en la composant, un peu comme la décohérence se manifeste comme résultat du parcours de tous les chemins possibles de l’univers, à la manière des intégrales de chemin de Feynman. De sorte que l’interaction est proprement sans lieu ni temps qui tous deux n’émergent qu’avec l’objet décohéré.
Durée spécieuse : le terme partage avec « spéculer » une même racine. Ainsi, la durée spécieuse est ce qui permet de voir dans le futur. Elle est un passé présent permettant une projection dans l’encore improduit à venir de suite. En jetant un pont entre le passé et l’à venir, elle détermine la figure de la durée : c’est cette sensation de continuité orientée que nous nommons durée.
Cette durée spécieuse ne se confonde pas avec le « temps », notion sans fondement. La durée n’est donc pas un glissement continu du réel. Elle n’est pas un long tapis roulant où s’empileraient, à la fois morts et vifs, on ne sait trop, les dinosaures et les anciens continents, les batailles du Moyen Age, les Empire engloutis, etc. Cette idée, qui n’est pas sans rapport avec celle de résurrection des corps à la fin des temps, est intenable : qu’on m’apporte, là, maintenant un morceau de passé ! Mais je veux dire du vrai passé : pas un os de dinosaure, mais un dinosaure vivant, avec les océans et les forêts carbonifères qui vont avec ! Qu’on m’amène un hénin, avec la dame en dessous, la musique, les trouvères, et les danses qui vont avec !
L’a-t-on jamais fait ? Le passé ne peut-être ! Seul l’instant est manifeste. Nous ne pouvons faire dire à notre animalcule : « voici mon histoire et celle de l’univers où j’ai évolué pour venir vous en parler .» Le temps ne peut être présupposé. Car sinon, on se retrouverait dans la situation suivante : j’affirme que la durée naît de la singularité, et grâce à cette construction je décris l’histoire de la singularité feignant de croire que je peux m’en abstraire.
Néanmoins, dès lors que je vous en parle, il me faut admettre qu’il existe quelque instance, confrontant le passé à l’à venir, comparaison dont j’espère qu’elle me permettra de maintenir le flux qui me permet de rester en vie. Pour cela je n’ai pas besoin d’inventer le temps.
Quelque chose d’une rémanence entourant la singularité tel un halo ou une aura suffit. Mais cette durée là n’est pas le temps. Son extension n’est pas celle du temps, mesurés en années, en battements du césium ou ce que l’on voudra, car elle précède la possibilité d’une métrique. Et la précédant elle confond facilement l’entendement qui y loge les milliards d’années qu’elle n’a pas encore crées, et ne crée en réalité pas du tout.
Une aura autour de la singularité suffit à contenir tous les devenirs possibles, l’histoire entière de l’univers, tous les souvenirs, tous le passé : oui, je touche des os de dinosaures, mais ce ne sont que des os au présent ! Au présent leurs empreintes dans la boue durcie !
L’image que je me forme dans mon esprit, du dinosaure broutant des pâtures énormes est par contre elle bien vivante. La mémoire artificieuse de tout cela, des ères disparus, des chevaliers et des gueux est bien convoquée là maintenant pour former image maintenant devant le miroir de mon esprit.
La durée est ce qui compare le manifesté dans l’instant à une forme synthétique subsumant les manifestés lors d’expériences « antérieures », formes engrammées dynamiquement, comme un réseau d’interférences entretenu dans quelque portion du percevant vivant. Il faut donc pour soutenir et construire la durée une instance de comparaison, maintenant présente: une mémoire.
Où pouvons nous la trouver sans nous égarer à inventer d’abord le temps ?
Chez l’animalcule, nous l’avons vu, cette instance de mémoire est déjà présente, embryonnaire, comme la nécessaire distance minimale, en deçà de laquelle rien de tel qu’un organite ne pourrait être reconnu, rien de telle qu’une singularité venant transformer localement les caractéristiques de l’univers.
Cette distance nous pouvons l’interpréter du point de vue de notre ciron, comme une différence de tension ou de niveau énergétique entre d’une part le corps de l’animalcule, et d’autre part le milieu qui le baigne.
C’est dans cette différence faible que toute la fable du temps se joue, contenant toute l’histoire de l’univers et de la vie, dans la trame de laquelle se tisse l’entendement qui ne réfléchit clairement qu’une fois achevée la fabrique alors que le virtuel s’opacifie tout à fait. C’est dans cette fulgurance que l’entendement nous berce de l’illusion du temps où se jouerait l’histoire.
[1] Voir Ethologie moderne de la girafe
Argiles
C’est de boue que le Golem est fait. Ce n’est pas sans raison que nombre de traditions désignent la glaise comme substance du vivant[1]. L’argile, on le sait est un empilement de « flocons » très ténus résultant de la décomposition de diverses roches mères. Elles se déposent en lits superposés au fond de mares ou de lagunes, constituant au fil des saisons et des âges des bancs de plusieurs mètres de puissance.
Certaines glaises particulièrement fines présentent des propriétés étonnantes. Elles ont en effet la particularité de répliquer, de film de dépôt en film de dépôt, et ceci à des niveaux de l’ordre de l’ångström, les accidents ou discontinuités affectant telle pellicule originelle. Ces solutions de continuité sont liées à une variété de cause tel l’effet tunnel quantique, la reptation atomique, ou encore à des accidents mécaniques, ou bien encore quelque dégradation chimique.
Ainsi l’information liée à l’accident originelle est-elle conservée et transmise, formant une lignée de discontinuités jusqu’à quelque nouvelle mutation atomique vienne l’interrompre et suscite peut-être quelque nouvelle bifurcation, qui de réplication en réplication, dessinera dans le massif argileux une forme d’arborescence.
Or il se trouve qu’on découvre lovées dans ces vacuoles nanoscopiques des molécules organiques. Il s’est ainsi formée l’hypothèse selon laquelle ces argiles fines constitueraient une sorte de proto-matrice de l’ADN, à l’abri de laquelle la double hélice se serait progressivement constituée avant que de s’autonomiser.
Le constat le plus intéressant est toutefois ailleurs : il concerne d’une part l’économie de la création de l’information initiale, et celle d’autre part de sa réplication et de son prolongement.
La première en effet se produit dans le plan – le film argileux saisonnier, la seconde concerne la masse tridimensionnelle du massif argileux. Et dans chacun des cas – planéité et volume – les forces en jeu sont fort différentes, irréductibles les unes aux autres.
Ainsi que l’accident générateur soit d’ordre mécanique, chimique ou le résultat d’une interaction avec le rayonnement cosmique, le vent, la pluie, le soleil, le ciel, les forces en jeu intéressent la régularité planaire du dépôt dont elles dérangent l’ordre initial. Le poids intervient peu, étant donné la ténuité des flocons argileux en cours de déposition. Plus généralement, l’environnement, susceptible d’agir sur telle particule donnée du dépôt en formation présente deux phases : l’une atmosphérique, dessus, et l’autre, dessous, argileuse, constituée des strates précédentes.
Une fois déposée, recouverte en enfouie au sein du môle argileux, la physique et la chimie de l’éventuel accident diffère profondément. Des influences nouvelles progressivement se font sentir : ainsi la masse du banc d’argile pèse désormais à plein. L’eau lessivant lentement la masse argileuse est saturée de sels minéraux. La vacuole n’est plus à la frontière de deux phases mais au contraire incrusté dans une masse relativement homogène et pleinement pesante. Il est désormais à l’abri des rayonnements cosmiques et solaires. Enfin, l’accident n’est plus ponctuel, mais dessine progressivement, par réplication, linéaments et arborescences.
Dans un cas comme dans l’autre, plan ou volume, les forces en jeu sont à la fois prévisibles, déterministes et aléatoires (c’est à dire stochastique). Gel et dégel, pluie et sécheresse, alternance du jour et de la nuit, rayonnement cosmique ou solaire, pesanteur, constituent des influences générales régulières et prévisibles.
Mais d’un autre côté, le lieu précis ou impactera le rayon cosmique, où interagira le photon, où surviendra telle désintégration, où le vent déposera la particule allogène déterminant l’accident initiant une série de réplications, ces influences là, dans un cas comme dans l’autre, restent, elles, parfaitement aléatoires.
Ainsi joue, tant dans le plan du film que dans la verticalité massive de la glaise deux ordres stochastiques de nature différente. Elles ne tiennent ensemble que par un point unique, au lieu où le plan de dépôt et ligne verticale (ou sub-verticale) des réplications se rencontrent.
Ainsi peut-on dire que la logique et la dynamique du dépôt et de la série des répliques est orthogonale. Ce qui signifie qu’au passage de l’horizontalité à la verticalité, ou encore du plan au volume est perdue toute une série d’informations.
Il serait ainsi possible d’enregistrer le moment auquel survient tel incident générateur, s’il fait alors du vent soufflant de quel orient et avec quelle force, s’il fait chaud ou bien froid, quel type de particule génère l’accident initial que les eaux dissoudront ensuite. Mais il me sera très difficile, voire impossible, quelques millions d’années plus tard de reconstruire, considérant la masse glaiseuse, les circonstances exactes ayant présidé à l’arborescence que je considère en coupe sous le microscope.
De manière similaire, au moment où se produit l’événement générateur, je n’ai aucun moyen de prévoir comment évoluera la série des répliques, à quels moments et où se produiront d’éventuelles bifurcations, si l’argile sous la masse empilée fluera courbant la lignée des copies, quelles influences tectoniques joueront, etc.
Présent et histoire, comme instant et durée, sont dans un rapport d’orthogonalité. Le présent est cette vaste plaine qui m’entoure de toute part et dont l’horizon fuyant manifeste l’absence de limites. Depuis le centre de l’espace local d’où je vois l’univers, son asymptote semble prendre la valeur de Planck. Quand à sa verticale, l’histoire, elle est inaccessible, simple fantasme, , rémanences actualisées constamment à la manière dont les lasers d’un night-club en structurent l’atmosphère enfumée et balaient la piste, ou encore à la façon dont le clapot résonne dans le golfe tandis que la mer bat. Car il faut bien une origine au flux d’où sourd l’instant tandis qu’autour s’étale une auréole de durée d’un rayon congru à la quantité de Planck. Mais cette origine n’est passée, mais constamment actuelle.
On ne peut que constater le présent. On ne peut le faire dériver de rien. Par exemple du temps, parce qu’il faudrait définir ce qu’il est, ce que personne ne sait faire. Toute théorie a pour base [2] le temps – ll faut du temps pour la concevoir, l’écrire, la lire, l’assimiler, l’utiliser – et ne saurait expliquer ce qui lui permet d’être. L’instant ne s’explique pas puisque sans lui je n’écris rien et vous ne lisez rien.
Présent et passé sont orthogonaux. Le présent n’est pas conséquence du passé mais son actualisation. A l’échelle universelle, il n’y a ni espace, ni temps, ni perte ni gain d’énergie ou d’information [3] . Cause et conséquence sont homogènes et contemporaines, passé et futur ont toujours existé – toutes les bibliothèques de cas sont contenus dans des nombre univers, mais le local suppose une orthogonalité au moins, un fond pour se singulariser.
Une base vectorielle valable doit être orthogonale afin de trier les évènements selon une grille fixe, à la manière de la quinconce des cellules basilaires de la cochlée ou le pavage irrégulier de la rétine du poulet. Percevoir implique au moins une orthogonalité, une bifurcation, un choix. La conséquence de ce jeté de dé, de regard excluant jeté sur le tout, de cette « hypothèse générale », est la perte d’une grande masse d’information perpendiculaire, tout comme dans l’argile industrielle malaxée on ne peut retracer le « temps » qu’il fit, brouillards, pluies, gels, lors de dépôts lagunaires saisonniers par exemple au moment du dépôt de chacun des flocons qui composent l’argile. Pourtant cette information n’est pas totalement perdue. Elle est dispersée et inaccessible, sauf par inférence[4].
[1] On peut s’interroger ici sur ces conjonctions extraordinaires qui font que les mythes semblent anticiper les découvertes les plus essentielles de la physique. Leucippe invente l’atome sans aucun moyen expérimental d’en obtenir quelque preuve, même indirecte. Vishnou, étendu sur l’onde, rêve le monde, préfigurant l’océan du vide quantique, dont la décohérence phénoménale construit le sensible. Toutefois, on peut tout aussi bien renverser les termes, et dire que les structures de la connaissance sont partout et toujours identiques, que les diverses époques emplissent des matériaux qui leur conviennent. Et comme toutes puisent à un seul et même univers, stable dans les lois de la phénoménalité dont l’observateur est lui-même partie prenante, il n’est pas si surprenant au fond que les théories s’accordent toujours aux phénomènes.
On peut encore dire ceci : la complexité du vivant perd son mystère si l’on admet qu’elle résulte de forces et de pressions simples, jouant toujours à toutes les strates de la complexification. De sorte que le mythe – celui de l’atome de Leucippe ou contemporain tel le big bang – tirent leur véracité de pression elles-aussi toujours renouvelées au travers de la complexification – dont l’une des expressions est l’appareil cognitif.
[2] Au sens de base vectorielle libre
[3] Ceci est une conséquence directe de l’axiome ontologique de l’instant source posé plus haut.
[4] L’une des orthogonalités dont il est fait cas ici concerne les nombres Zétas : l’axes des zéros « triviaux » de l’équation est perpendiculaire à celui des zéros non triviaux dont la distribution évoque celle des nombres premiers.

